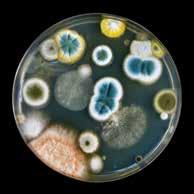
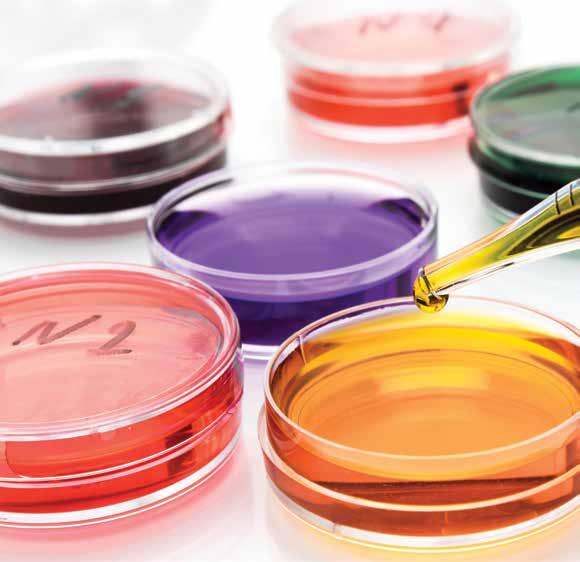

The University of Pretoria congratulates all our academic achievers.
![]()

The University of Pretoria congratulates all our academic achievers.
Dr
Acknowledgements
Portraits in this publication are by Eyescape Studios. Other photographs were supplied by Shutterstock and Lucinda du Toit Photographic D’Art. The UP Language Unit is acknowledged for sub-editing and translation services rendered. Design and layout: Liana Schröder, Department of University Relations.

As we celebrate the outstanding performance of our academic staff and pay tribute to their commitment and hard work, we also acknowledge the important contributions they make to our academic mission. The academics featured on these pages contributed to the University being ranked one of the top research institutions globally, through their pursuit of excellence in research, teaching and learning and community engagement. As a testimony to this, UP was recently ranked by QS in the top 2% of universities worldwide, entrenching our position as one of the top 26 000 universities globally.
Congratulations to our academic achievers, all others honoured by the University for various contributions and the academics who were successfully rated by the National Research Foundation. We are proud of you and wish you every success as we look ahead to the social and economic impact you will make on our communities, locally and internationally.
Terwyl ons die uitstaande prestasie van ons akademiese personeel vier en hul toewyding en harde werk vereer, erken ons ook hul belangrike bydraes tot ons akademiese missie. Deur hul strewe na uitnemendheid in navorsing, onderrig en leer en gemeenskapsbetrokkenheid, het die akademici wat op hierdie bladsye verskyn, daartoe bygedra dat die Universiteit as een van die top navorsingsinstellings wêreldwyd gereken word. As bewys hiervan is UP onlangs deur QS in die top 2% van universiteite wêreldwyd aangeslaan, wat ons posisie as een van die top 26 000 universiteite wêreldwyd vaslê.
Baie geluk aan ons akademiese presteerders, aan almal wat vir verskeie bydraes deur die Universiteit vereer is en aan die akademici wat suksesvol deur die Nasionale Navorsingstigting gegradeer is. Ons is trots op u en wens u alle sukses toe terwyl ons uitsien na die sosiale en ekonomiese impak wat u op ons gemeenskappe, plaaslik en internasionaal, sal maak.
Ge re keteka mošomo wo mobotse kudu wa badirišani ba rena ba thuto gomme re hlompha boikgafo bja bona le go šoma ka maatla, re amogela gape tema ye ba e kgathago ye bohlokwa go maikemišetšo a rena a thuto. Dirutegi tše di tšwelelago matlakaleng di kgathile tema gore Yunibesithi e lekanyetšwe go ba ye nngwe ya diinstitušene tša godimo lefaseng ka moka, ka go tšwetša pele bokgoni mo dinyakišišong, go ruteng le go ithuteng le go tšea karolo setšhabeng. Bjalo ka kgonthišo ya se, UP kgauswanyana e lekanyeditšwe ke QS mo go 2% ya godimo ya diyunibesithi mo lefaseng, ya thea maemo a rena bjalo ka ye nngwe ya diyunibesithi tše 26 000 tša godimo lefaseng.
Re lebogiša bašomedi ba rena ba thuto bao ba atlegilego, ka moka bao ba hlomphilwego ke yunibesithi ka go kgatha tema ga go fapana le dirutegi tšeo di lekanyeditšwego ka katlego ke Motheo wa Dinyakišišo wa Setšhaba. Re ikgantšha ka lena gomme re le lakaletša katlego ge re lebeletše khuetšo ya leago le ekonomi yeo le tla e dirago ditšhabeng tša rena mo gae le ditšhabatšhabeng.
Vice-Chancellor and Principal | University of Pretoria Visekanselier en Rektor | Universiteit van Pretoria Motlatšamokhanseliri le Hlogo | Yunibesithi ya Pretoria

Professor Bawa is a theoretical physicist. He currently holds the position of Chief Executive Officer of Universities South Africa (USAf). Professor Bawa was Vice-Chancellor and Principal of Durban University of Technology until the end of April 2016. Before August 2010 he was a faculty member at Hunter College in the City University of New York where he was a member of the Department of Physics and Astronomy and a member of the doctoral faculty at the Graduate Center. During this period he was Associate Provost for Curriculum Development at Hunter College.
He had previously, for about nine years, held the position of Deputy Vice-Chancellor at the University of Natal and then at the University of KwaZulu-Natal. He has served as the Program Officer for Higher Education in Africa with the Ford Foundation and during this time led and coordinated the Foundation’s African Higher Education Initiative. At the time he worked closely with, among others, the Association of African Universities and the Council for the Development of Social Research in Africa.
Professor Bawa holds a PhD in Theoretical Physics from the University of Durham, UK. He has published in the areas of high energy physics, nuclear physics, higher education studies, science education and, to some extent, in the area of science and society.
He served on a number of policy development teams in the post-1994 period and was an inaugural member of the National Advisory Council on Innovation till 2002. He is a Fellow of the Royal Society of South Africa as well as the Academy of Science of South Africa of which he was one of the inaugural vice-presidents. He served as Chair of the Board of the Foundation for Research Development, served on the board of the National Research Foundation and was vice-chairperson of the board of the Atomic Energy Corporation. He serves on several international advisory boards.
Chief Executive Officer of Universities
South Africa (USAf)
Hoof Uitvoerende Beampte van Universiteite
Suid-Afrika (USAf)
Mohlankedimogolo-phethiši wa Diyunibesithi tša
Afrika Borwa (USAf)

Kanseliersmedalje | Navorsing
Sefoka sa Mokhanseliri | Dinyakišišo
The Chancellor’s Award is made in recognition of exceptional achievement in the field of research aimed at the advancement of science and the associated promotion of the interests of the University of Pretoria.
Die Kanselierstoekenning word gemaak vir uitnemende prestasie op navorsingsgebied ter bevordering van die wetenskap en sodoende ook die belange van die Universiteit van Pretoria.
Sefoka sa Mokhanseliri se diretšwe go leboga phihlelelo ya go tšwelela ka magetla mosomong wa bonyakišiši woo maikemišetšo a wona e lego go hlabolla le go godiša dikgahlego tša Yunibesithi ya Pretoria.
Chancellor | University of Pretoria
Kanselier | Universiteit van Pretoria
Mokanseliri | Yunibesithi ya Pretoria


Professor Bennett is a Professor of Zoology at the University of Pretoria and also occupies the Department of Science and Technology/National Research Foundation (NRF) Research Chair in the field of Mammalian Behavioural Ecology and Physiology and the UP Austin Roberts Chair of African Mammalogy.
Professor Bennett’s research focus is on ecology, animal physiology and behaviour using the African mole-rat as his model animal. He is the world leader in African mole-rat biology, in particular reproductive physiology. He and his co-workers have investigated the ecological and physiological factors that affect the control of reproduction and the evolution of sociality. Unlike other researchers investigating cooperative breeding in mammals, he has done so from a variety of perspectives. The strength of this multi-faceted approach is that it has led to an integrated understanding of reproductive suppression in mole-rats of a type that has not been achieved for any other taxa or group of taxa. His research has set the benchmark for our understanding of phylogenetic and ecological constraints regulating reproductive success and social evolution in mammalian species.
His research record ranks him among the best researchers studying social regulation of reproduction in any group of mammals in the world. Professor Bennett obtained his BSc Hons in 1983 from the University of Bristol in the United Kingdom (UK). After completing his PhD at the University of Cape Town (UCT) in 1988 he was employed as a junior lecturer and senior researcher in zoology at the institution until 1995 when he was appointed as a senior lecturer in the Department of Zoology and Entomology at UP. He was promoted to full professor in 2001.
Professor Bennett holds an A rating from the National Research Foundation. He has been a visiting professor at the School of Chemical and Biological Sciences, Queen Mary College, University of London since 2005 and more recently a visiting professor at the Department of Zoology, King Saud University, Saudi Arabia. He is a Fellow of the Zoological Society of London, a Fellow of the Royal Society of South Africa and a member of the Academy of Sciences of South Africa. He received a gold medal from the Zoological Society of Southern Africa and the Havenga Prize for outstanding contributions to Life Sciences awarded by the Akademie vir Wetenskap en Kuns.
He received the University of Pretoria Commemorative Research Medal for being one of the top 100 scientists in 100 years of its existence in 2008. He has been awarded the UP Chancellor’s Medal for his research twice as well as receiving the Exceptional Academic Achiever Award for the past 16 years. In 2015 he was awarded an NSTF Eskom-sponsored award for his outstanding contribution to Science, Engineering and Information Technology as a developer of research capacity. In 2016 he was made a Fellow of the African Academy of Sciences and in 2017 the University recognised him with the Vice-Chancellor’s award for outstanding postgraduate supervision. Professor Bennett has served as president of the Zoological Community of Southern Africa for two years. He is editor-in-chief of the Journal of Zoology and a past editor of Proceedings of the Royal Society of London Biological Sciences B. In 2013 he took on the handling editor position at Biology Letters another Royal Society journal. Professor Bennett has published 345 papers in international peer-reviewed scientific journals, co-authored a specialist book published by Cambridge University Press and has penned twelve chapters in books.

Visiekanselier se Boektoekenning 2017
Difoka tša Puku tša Motlatšamokhanseliri tša 2017
The University of Pretoria introduced the Vice-Chancellor’s Book Awards to recognise and reward authors of scholarly books, monographs and collections. The prizes are awarded once a year in two categories, namely humanities and social sciences (broadly defined) or natural and applied sciences. In 2017 only one award, in the humanities and social sciences, was made. A book is considered to be scholarly if it presents the findings of an original, systematic investigation undertaken to gain new knowledge and insight, advances knowledge in a particular discipline and brings credit to the University. Scholarly books may be written in any of South Africa’s official languages and translations of major works originally published in other languages are also considered. In order to qualify for nomination, books should bring credit to the University on account of their contribution to the advancement of the humanities, the social sciences or the natural and applied sciences.
Die Universiteit van Pretoria het die Visekanselier se Boektoekennings ingestel om skrywers van vakkundige boeke, monografieë en versamelings te beloon. Die pryse word een keer per jaar in twee kategorieë toegeken, naamlik die geestes- en sosiale wetenskappe (breed gedefinieer) en die natuur- en toegepaste wetenskappe. In 2017 is net een toekenning, in die geestes- en sosiale wetenskappe, gemaak. ʼn Boek word as vakkundig beskou as dit die bevindings van ʼn oorspronklike, stelselmatige ondersoek aanbied wat gedoen is om nuwe kennis en insig te bekom, kennis op ʼn bepaalde vakgebied uitbrei en die Universiteit eer besorg. Vakkundige boeke kan in enige van Suid-Afrika se amptelike tale geskryf wees en vertalings van belangrike werke wat oorspronklik in ander tale uitgegee is, word ook oorweeg. Om vir benoeming in aanmerking te kom, moet boeke die Universiteit tot eer strek op grond van hul bydrae tot die vooruitgang van die geestes- en sosiale wetenskappe of die natuur- en toegepaste wetenskappe.
Yunibesithi ya Pretoria e tsebagaditši Difoka tša Dipuku tša Motlatšamokhanseliri go lemoga le go leboga bangwadi ba dipuku tša thuto, ditaodišo le dikgoboketšo. Difoka di abja gatee mo ngwageng ka magoro a mabedi, e lego, la bomotho le disaense tša leago (le hlalošwa ka bophara) le disaense tša tlhago le tirišo. Ka 2017 go abilwe sefoka se tee, ka bomothong le disaense tša leago. Puku e tšewa go ba ya thuto ge e tšweletša dikutollo tša mathomong, dinyakišišo tša peakanyo di dirilwe go hwetša tsebo ye mpsha le kwešišo, tsebo ye e tšweletšego mo karolong ye e itšego gomme ya tumiša Yunibesithi. Dipuku tša thuto di ka ngwalwa ka dipolelo tša semmušo tša Afrika Borwa gomme diphetolelo tša mošomo wo mogolo woo mathomong o phatlaladitšwego ka dipolelo tše dingwe le tšona di a lebeledišišwa. Gore o be le maswanedi a go kgethwa, dipuku di swanetše go tumiša Yunibesithi mo go tšeeng karolo ga yona go tšweletšopele ya bomotho, disaense tša leago goba disaense tša tlhago le tirišo.



Dr Brits is a remarkable young researcher who has written this very important book as a single author. The book covers a critical area of the law, namely the law relating to real security, a central aspect of the law for financing and banking. As the only current scholarly work on the topic, this book fills a void in this important branch of the law. Dr Brits has succeeded in providing a thorough, critical discussion of the various forms of real security provided for by South African law, through a contemporary and constitutional lens. For the informed reader and scholar, the book also contains valuable comparative perspectives with reference to a number of important developments in other jurisdictions.
It is notable that this book has (within a year of publication) attracted the attention of the Constitutional Court in a recent and important judgment in a case dealing with the interpretation of section 118(3) of the Local Government: Municipal Systems Act, 32 of 2000. This provides a mechanism to enforce the payment of historical debts owed by property owners to municipalities. In settling this challenging legal issue, the Constitutional Court endorsed Dr Brits’ arguments in its judgment.
The book has the potential to become a key reference work in this important area of the law.

Uitnemende Akademiese Presteerders
Bašomedi bao ba Atlegilego Kudu: Diakatemiki
This award is made annually to senior academics who have already achieved the status of professor, are regarded highly by their peers and have consistently excelled in the areas of under- and postgraduate teaching and learning, research, community service and administration over a period of time. Any academic who has been awarded an A rating by the NRF in the year under consideration automatically qualifies as an Exceptional Achiever for as long as he or she remains an A-rated researcher.
Dié toekenning word jaarliks aan senior akademici gemaak wat reeds professorale status verwerf het, besonder hoë statuur onder hulle eweknieë geniet en oor ‘n geruime tydperk volgehoue uitnemende prestasies op die gebied van voor- en nagraadse onderrig en leer, navorsing, gemeenskapsdiens en administrasie behaal het. Enige akademikus wat deur die NNS as ‘n A-gegradeerde navorser geëvalueer is, in die jaar onder oorweging, word outomaties ‘n Uitnemende Presteerder vir so lank as wat hy of sy die status van ‘n A-gegradeerde navorser behou.
Sefoka se se abelwa bafahloši bao ba lego maemong a godimo a seakatemiki ebile ba šetše ba fihleletše maemo a boprofesa gomme ba hlompšha ke ba mephato ya bona gape ba tšwelapele go šoma ka bothakga ka magorong a go ruta le go ithuta go baithuti ba maphoskratšuweiti le go bao e sego maphoskratšuweiti, dinyakišišong, tirelong ya setšhaba le tshepedišong godimo ga nako ya go bonala. Mofahloši o mongwe le o mongwe yo a fihleletšego maemo a NRF a (A) o kgotsofatša dinyakwa tša go tsenela legoro la Moatlegi wa go Tšwelela ka Magetla ka dinako ka moka ge a ntše a le monyakišiši wa maemo a (A).

Professor Bornman is professor and Director of the Centre for Augmentative and Alternative Communication (CAAC) in the Faculty of Humanities. Her research investigates disability — specifically severe communication disability — as a multi-dimensional phenomenon that arises from the interaction between a person’s health status and their physical, social and attitudinal environment. She professes that in the disability field, the scholar can never be a passive onlooker — it requires commitment and passion for ‘gently shaking the world’ as described so aptly by Gandhi. Hence, a human rights-based approach towards communication rehabilitation with a sustainable, contextually relevant framework is the focal point of her scholarly endeavours.
Communication represents an essential human need as well as a basic human right as it enables humans to exchange opinions, thoughts and meaning. It makes us who and what we are and validates human equality. The ability to communicate is essential to forging relations, interacting with one another and helping to break down barriers that impede growth and development. However, this is not always easy for persons with severe communication disability who cannot rely on spoken language to express themselves. The Convention on the Rights of Persons with Disability (UN, 2009) focusses on the promotion and protection of the human rights and fundamental freedoms of all persons with disabilities, including those individuals who require more intensive personal support in order to promote respect for their inherent dignity. Her recent research comprised two main foci related to the Convention — one on children, and one on adults (each comprising six studies).
She was the South African primary investigator for three substantial international collaborative research grants, namely ICF-CY: A common language for understanding the multidimensional construct disability in childhood with Professor Mats Granlund from Jönköping University; Developmental Assessment across Languages and Cultures: A preliminary study with Professor MaryAnn Romski from Georgia State University; and Using Mobile Health Technology to Optimize Communication Outcomes for South African Children with Developmental Disorders, a follow-up of the assessment mentioned secondly, also with Professor Romski.
Her work attracts attention on the African continent from specifically Ethiopia, Kenya and Lesotho, as well as the United States, Sweden, Portugal and Australia. In the light of the fact that these countries have long histories of human rights for persons with disability and well-established knowledge and skills about AAC, her international recognition is significant. At the 17th Biennial AAC conference in Toronto in 2016, she was awarded a Fellowship by the prominent International Society for AAC for outstanding and distinguished achievement in the field of AAC. On this occasion Professor R Sevcik remarked that ‘her work has drawn substantial attention both within South Africa as well as from international audiences around the world’. In the past eight years, Professor Bornman has written 43 peer-reviewed papers as sole or co-author, mostly with international peers. These have mostly been published in ISI-accredited journals, with some in DHET journals. In this period she has also co-authored two books, four book chapters, and was invited to write three chapters in international books that are currently in press. Writing as a co-author with leading international experts in the field has been an integral part of building a relatively new discipline (AAC) in South Africa, and developing innovative postgraduate training. She presented her research findings at lectures, conferences and meetings, often as invited keynote speaker. Prof Bornman is the Director of the Centre for Augmentative and Alternative Communication and her team won the prestigious Reimagine Education 2016 Regional Awards for Africa, representing a firm alignment between Professor Bornman’s scholarly work and pedagogical innovations in respect of research and the relationship to teaching practice. The research impact of her work has direct bearing on direct service delivery — in 2014 her team received the HAMLET Outstanding Achievement Award for service delivery to persons with severe communication disabilities.

Professor Botha is professor and Head of the Department of Paraclinical Sciences, Faculty of Veterinary Science. As a veterinary toxicologist, Professor Botha investigates plant poisoning and mycotoxicoses affecting livestock in southern Africa. South Africa has the richest temperate flora in the world, including numerous potentially poisonous plants. Furthermore, many exotic and invasive plant species have become naturalized in South Africa. To date, some 600 potentially poisonous plant species have been identified. Since many of the poisonous plants only occur in southern Africa, we have to find answers to the problems that they cause. Investigating plant poisonings in southern Africa is therefore imperative, both to increase our knowledge and to advise farmers on how to deal with poisoning when it occurs. Besides the scientific documentation of new and lesser known plant poisoning and mycotoxicoses, research questions are addressed that contribute novel, original or additional scientific data to this field.
Professor Botha is a co-author of the second edition of the standard textbook Plant Poisonings and Mycotoxicoses of Livestock in southern Africa. The textbook will soon be available online in a digital format. He also works as a consultant at the Veterinary Toxicology Laboratory, Onderstepoort Veterinary Institute, where he is involved in toxicology diagnostics that offer the opportunity for applied research.
Professor Botha is involved in aspects of environmental/aquatic toxicology research. He was the coordinator of a collaborative research project in environmental toxicology on evaluating the use of biomarkers in African sharptooth catfish (Clarias gariepinus) as an indication of pollution in selected aquatic ecosystems in Mozambique, South Africa, Tanzania and Uganda. The African sharptooth catfish that occurs in freshwater bodies in all the collaborating countries, was identified to be used as sentinel to scan for aquatic pollution by persistent organic pollutants (POPs). Later the emphasis shifted to cyanobacterial and cyanotoxin research. Professor Botha is registered as a veterinary specialist (Toxicology) with the South Africa Veterinary Council, a Fellow of the American Academy of Veterinary and Comparative Toxicology and a member of the South African Veterinary Association.
Professor Botha holds a B1 rating from the NRF.

Professor Heyns is Professor of Human Rights Law and Director of the Institute for International and Comparative Law in Africa at the University of Pretoria. He holds teaching positions at Oxford University, the American University in Washington DC and the Geneva Academy on International Humanitarian Law and Human Rights. He was visiting professor at the University of Geneva in 2017.
Professor Heyns is an internationally recognised expert in the field of human rights, with a special focus on the right to life. He is also an authority on the African regional human rights system. Professor Heyns combines his academic work with international legal practice. In 2016 he completed a six year term as United Nations Special Rapporteur on extrajudicial, summary or arbitrary executions, the premier position in the UN on the protection of the right to life. During the same year he served as the Chair of the United Nations Independent Investigation on Burundi, investigating the violence that occurred in that country after the 2015 elections. He currently serves as a member of the UN Human Rights Committee, the body that monitors the implementation of civil and political rights. The Committee is currently engaged in drafting a General Comment (authoritative interpretation) on the right to life.
Working with a global team of policing, forensic and legal experts, Professor Heyns was the main author of the updated Minnesota Protocol on the investigation of potentially unlawful death (2016) — the gold standard worldwide for autopsies and death investigations. He was one of two experts tasked by the Human Rights Council to conduct research worldwide and to develop guidelines on the management of demonstrations in the aftermath of the so-called Arab Spring. These guidelines, adopted in 2016, are now the leading UN text on the subject. He served as consultant to the African Union’s Commission on Human and Peoples’ Rights when the latter drafted their General Comment on the right to life.
Many of Professor Heyns’s recent academic publications draw on his work with the United Nations and the African Union. He submitted various reports to the UN on the international law framework for the use of armed drones. He co-wrote an article on the topic with Oxford Professor Dapo Akande, which was selected as Article of the Year by the International and Comparative Law Quarterly by Cambridge University Press in 2017.
A report by Professor Heyns put the challenges posed by the emergence of autonomous weapons — ‘killer robots ’ — on the UN agenda, and in subsequent years he served as expert advisor to the Committee on Conventional Weapons on the topic. He published widely on the same topic in leading academic journals and text books, arguing that fully autonomous weapons should be banned. Much of his practical and academic work has focused on the use of force by the police and the death penalty. He is currently leading a process with the Geneva Academy to develop international standards on the use of so-called ‘less lethal weapons’ (rubber bullets, etc). He has appeared in and submitted expert opinions to various courts during death penalty proceedings. He pioneered the position in the UN that international law requires at least the gradual abolition of the death penalty. In South Africa he served as an expert witness to the Marikana inquiry. In 2016 he was awarded the Don and Arvonne Fraser Human Rights Award by the Advocates for Human Rights, Minnesota, Minneapolis. Professor Heyns is currently establishing a project at UP on ‘Freedom from violence in Africa’, working with the Faculties of Health Sciences and Engineering, Built Environment and Information Technology. Together with Professor Frans Viljoen, Director of the Centre for Human Rights at UP, he is conducting a study in collaboration with the UN on the impact of the United Nations human rights treaties worldwide which involves working with experts who are conducting on-site studies in 20 countries.

Professor Skelton holds a BA LLB from the University of KwaZulu-Natal and a doctorate in law from the University of Pretoria. She is currently the Director of the Centre for Child Law, the holder of the UNESCO Chair in Education Law in Africa, and a professor in the Department of Private Law, Faculty of Law, University of Pretoria. Professor Skelton has worked as a children’s rights lawyer in South Africa for over 25 years. She founded the Lawyers for Human Rights office in Pietermaritzburg in 1988 and worked there for 11 years. She moved to Pretoria in 1999 to head a UN technical assistance project on child justice, before moving to the Centre for Child Law in 2004. There she established the strategic litigation project, before being promoted to Director in 2008.
Professor Skelton played a leading role in child law reform through her involvement with the committees of the South African Law Reform Commission. She chaired the committee that drafted the Child Justice Act and was a member of the committee that drafted the Children’s Act. She is an internationally recognised researcher, with a B2 rating from the NRF, and has published widely in child law and restorative justice. Her fields of research span a wide range of child law matters, as well as a focus on restorative justice. She has an impressive publishing record.
In addition to her more traditional research outputs, Professor Skelton’s research has had a unique impact through strategic litigation. This entails applying the research through court papers and oral argument in landmark cases in the courts. Prof Skelton has appeared as counsel in ten Constitutional Court cases, five Supreme Court of Appeal cases and numerous High Court matters. The tangible output of her research is captured in precedent-setting judgments in winning cases, and the embedding of the research into South Africa’s jurisprudence.
In 2012 she received the Worlds’ Children’s Honorary Prize presented by the Queen of Sweden. In December 2016 she was awarded the Juvenile Justice Without Borders Award presented by the International Observatory on Juvenile Justice in Paris, in recognition of her more than 20 years of work on children in the criminal justice system. In the same year she was appointed to the advisory committee guiding the United Nations Global Study on Children Deprived of their Liberty.
Professor Skelton has been a member of the United Nations Committee on the Rights of the Child since 2017. She was nominated by the South African government and voted in by a majority of UN member states. This international treaty body sits three times a year in Geneva and monitors state compliance with the Convention on the Rights of the Child. Professor Skelton’s appointment to this committee as an independent expert attests to recognition at the highest level of the contribution she has made to children’s rights, not only in South Africa, but globally.

Uitnemende Jong Navorsers
Banyakišiši ba baswa bao ba Atleilego Kudu
This award is given to exceptional young achievers in the field of research, as seen against the University’s strategic goals of achieving academic excellence, international competitiveness and local relevance. Any person who has been evaluated by the NRF as a P-rated researcher automatically enjoys Exceptional Young Researcher status.
Hierdie toekenning word op grond van uitnemende prestasie aan jong akademici op die gebied van navorsing gemaak, gesien in die lig van die Universiteit se strategiese doelwitte van akademiese uitnemendheid, internasionale mededingendheid en plaaslike relevansie. Enige persoon wat deur die NNS as ‘n P-gegradeerde navorser geëvalueer word, verkry outomaties die status van ‘n Uitnemende Jong Navorser.
Banyakišiši ba baswa ba go Atlegilego go fetiša Sefoka se se abelwa baatlegi ba go tšwelela ka magetla lekaleng la dinyakišišo, bjalo ka ge go laeditšwe ka lenaneong la maano a Yunibesithi a go fihlelela bothakga, phenkgišano ya boditšhabatšhaba le maswanedi a selegae. Motho mang le mang yo a lekotšwego ke NRF bjalo ka monyakišiši wa maemo P o kgotsofatša dinyakwa tša gotsenela legoro la Monyakišiši o Moswa wa go atlega go fetiša.
Dr Helbig is a senior lecturer in the Department of Computer Science in the Faculty of Engineering, Built Environment and Information Technology (EBIT).
Her research focusses on solving dynamic multi-objective optimization (DMOO) problems using computational intelligence techniques. DMOO problems have more than two objectives where at least two of them are in conflict with one another. Improving on one objective results in worsening at least one of the other objectives. Furthermore, at least one of the objectives changes over time. Therefore, a single solution does not exist and the goal of the algorithm is to find the set of optimal trade-off solutions.
Dr Helbig is very active in the computational intelligence community and serves as vice-chair of the IEEE Computational Intelligence Society (CIS) task force on evolutionary multi-objective optimization, member of the IEEE CIS Emerging Technologies Technical Committee, and member of the IEEE CIS Women in Computational Intelligence and the IEEE CIS Young Professionals subcommittees. She has organized numerous special sessions and delivered tutorials on DMOO at top conferences in the field. She has also delivered four keynotes at international conferences in the last two years.
She received an Y1 rating from the NRF in 2016. In 2017 she was selected as a member of the South African Young Academy of Science (SAYAS), as well as a member of the executive committee.
MARDÉ HELBIG

Professor Krüger is an associate professor in the Department of Physics in the Faculty of Natural and Agricultural Sciences. He is passionate about multidisciplinary research and performs his own research in molecular biophysics, a field at the confluence of physics, biology, chemistry, mathematics, statistics, and even information technology and engineering.
His main interest is to resolve the molecular details of energy transfer and regulation in the light-harvesting complexes of various photo-synthetic organisms, and to control these processes using shaped light and nanoparticles. He also investigates novel materials for bio-inspired solar technologies. One such project is the design of minimal protein-based light-harvesting complexes that can perform pre-programmed tasks. He designs and builds new spectroscopic equipment, such as single-molecule spectroscopy and femtosecond laser spectroscopy, to push the optical resolution to the technological limits.
Professor Krüger believes that the best way to grow his research is to invest in postgraduate supervision. He currently supervises two postdoctoral, seven PhD and five MSc students. He also has an extensive international collaborative network, which includes one of the 2014 Nobel laureates in Chemistry.
Prof Krüger has received a substantial grant from the NRF’s prestigious National Equipment Programme, has written several invited review articles and book chapters, and is the co-author of an advanced textbook on optical spectroscopy. In 2015 he received a Fellowship from the Freiburg Institute for Advanced Studies, in 2016 he was awarded a Y1 rating from the NRF and in 2017 he was shortlisted for the Azrieli Global Scholars Program of the Canadian Institute for Advanced Research. He is currently chair of the South African Biophysics Initiative.

Dr Mayaphi holds a joint appointment as a senior lecturer/pathologist in the Department of Medical Virology in the Faculty of Health Sciences and National Health Laboratory Service – Tshwane Academic Division (NHLS – TAD). He is involved in teaching and training of both undergraduate and postgraduate students, the provision of virology laboratory services to the public health care sector, and supporting the National Department of Health with advice on national guidelines in his area of speciality.
Dr Mayaphi’s research focus is in line with the global health and South African government health priorities as it mainly revolves around understanding the basic science, epidemiology and management of HIV and related opportunistic infections. His research work is published in ISI-rated peer-reviewed journals, and presented at local and international conferences. His publications include research on the impact of HIV on the hepatitis B virus (HBV) and cytomegalovirus (CMV), which are viral opportunistic infections of relevance to South Africa and many developing countries.
He is currently working towards completion of his PhD degree at the University of Pretoria. His PhD project is on the detection and characterisation of acute and early HIV infections (ie window period infections), which are often misdiagnosed by rapid HIV tests used at the clinics. The research outputs from his PhD project shed some light on a practical and affordable diagnostic approach for acute and early HIV infections in resource-limited settings; and on the relevance of standardising HIV risk behaviour data collection during HIV counselling and testing in order to obtain data that can inform implementation of appropriate HIV prevention services to communities. His PhD research data also point to the transmission of antiretroviral (ARV) drug-resistant strains of HIV in the Tshwane region, a finding which has implications for revision of the first-line ARV regimen used in South Africa. The collaboration that Dr Mayaphi forged with various local and international researchers has contributed significantly to his research outputs. He has supervised the projects of four master’s and two honours students.
Dr Mayaphi has been a recipient of a number of prizes in recognition of his research work. He is a recipient of a prestigious research funding, the Hamilton Naki Clinical scholarship, which has allowed him to dedicate more time to his PhD studies.
He has received awards for best publications as adjudicated by external reviewers from the Faculty of Health Sciences. He has also received awards for best presentations at conferences and the Faculty of Health Sciences Research Day.

Dr Mizrachi is a senior lecturer in the Department of Biochemistry, Genetics and Microbiology, in the Faculty of Natural and Agricultural Sciences. He is part of the Forest Molecular Genetics (FMG) Programme, in the Forestry and Agricultural Biotechnology Institute (FABI), and is also affiliated with the Genomics Research Institute (GRI).
His research group studies the molecular biology and evolution of wood formation in trees, and the synthesis of specialized biopolymers in the secondary cell wall of vascular plants. Their research deals with fundamentals, such as how gene and genome duplications have contributed to the evolution and adaptation of plants, and how a plant cell regulates, apportions and converts large supplies of carbon (in the form of sugar) for the synthesis into different plant cell wall biopolymers. The research also has strong application in the forestry and other plant biomass-related industries, where the ultrastructure and composition of secondary cell walls have direct industrial and economic implications. His group uses genomics technologies for the construction and analysis of comprehensive gene catalogues from ‘missing link’ plant species with no prior genome sequence information, such as ginkgo, cycads and horsetails. They also apply systems biology and systems genetics approaches to model the regulation of wood development and secondary cell wall biosynthesis.
He has authored 23 publications that have accumulated over 900 citations, with an average impact factor of 8.8 and an h-index of 12. Many of these publications are in top ranked plant biology and biotechnology journals (including two invited reviews), as well as some in top tier general science journals such as Nature, PNAS and Nature Reviews Genetics. Dr Mizrachi lectures third year and BSc honours modules, in the areas of gene and genome evolution, plant biology and biotechnology, and systems biology.
Outside of his core research he is involved in leadership training of scientists and serves on the steering committee of the Africa Science Leadership Programme, a programme of Future Africa, now in its fourth year and connecting more than 80 early career researchers across the continent. Within the University, he is involved in organization of the Tuks Young Research Leader Programme (TYRLP), also in its fourth year, which is creating a community of young researchers in the University who are mindful of emphasising collective leadership, high impact transdisciplinary research and science communication.
ESHCHAR MIZRACHI

Visekanselier se Toekenning vir Uitnemende Studieleiding
Sefoka sa Batlatšabakhanseliri sa Bokgoni bja Bolekodi
This award recognises the contribution of members of our academic staff who excel as supervisors of postgraduate research students. The award is made on the grounds of exceptional performance measured in terms of the students’ academic achievement. Evidence of excellent mentorship and guidance provided to young researchers and academic scholars are also taken into consideration.
Hierdie toekenning gee erkenning aan die bydrae van ons akademiese personeel wat uitblink as toesighouers van nagraadse navorsingstudente. Die toekenning word gedoen op grond van besondere prestasie gemeet aan die studente se akademiese prestasie. Bewyse van uitstekende mentorskap en leiding aan jong navorsers en akademiese vakkundiges word ook in ag geneem.
Difoka tše di lemoga tema yeo e kgathilwego ke maloko a badirišani ba thuto bao ba šomilego gabotse bjalo ka balekodi ba baithuti ba nyakišišo ya dialogadigolwane. Difoka di dirwa ka mabaka a phethagatšo ya go ikgetha yeo e lekanywago go ya ka diphihlelelo tša thuto tša baithuti. Bohlatse bja tlhahlo ye botsebotse le tlhahlo ye e filwego banyakišiši ba bafsa le baithuti ba thuto le bona ba lebeledišišwa.

Professor Birkholtz is a professor in Biochemistry in the Department of Biochemistry, Genetics and Microbiology. She is the current incumbent of the DST/NRF South African National Research Chair (SARChI) in Sustainable Malaria Control. As part of the Institute for Sustainable Malaria Control (UP ISMC) she directs the Parasite Control Cluster as a MRC Collaborative Centre for Malaria Research, and her programme comprises two academic staff members, five postdoctoral Fellows and three research staff members. Professor Birkholtz also heads the South African Malaria Transmission-blocking Consortium (SAMTC, a joint venture with the Council for Scientific and Industrial Research and the University of the Witwatersrand) focussed on drug discovery for malaria elimination with the University of Cape Town. This year, a NRF Community of Practice was established under Professor Birkholtz’s leadership, coalescing the efforts of five SARChI Chairs towards malaria elimination.
Professor Birkholtz has had significant success as a postgraduate student supervisor, graduating a total of 14 PhD, 24 MSc and 38 honours students in the past five years. The remarkable aspect of Professor Birkholtz’s achievements in supervision to date is the excellence of her supervisory contribution, as demonstrated in the throughput rates, the number of distinctions (12 of her 24 MSc students graduated with distinction) and the large proportion of her students who have been awarded bursaries to further their studies. An impressive number of her postgraduate students have received NRF Innovation Bursaries and Scarce Skills Awards, or have been recognised at national and international conferences through prizes for best oral or poster presentations. Of her PhD students have continued with postdoctoral Fellowships at Yale, Pennsylvania State University and Emory University in the USA.
Her involvement with her students in research publication is also impressive, with 25 of her 39 papers published in high-impact journals during this period having been co-authored by postgraduate students. Professor Birkholtz obtained all her undergraduate and relevant postgraduate degrees with distinction and is herself an established researcher with a current B rating from the NRF.
Professor Birkholtz’s research is focused on the physiology, biochemistry and pharmacology of malaria parasites. Her work finds biochemical distinctions between the malaria parasite and the human host, which are exploitable for the design of novel antimalarial chemotherapeuticals as transmission-blocking drugs. Her team has pioneered the use of large functional genomics datasets to support drug discovery for malaria elimination. As an NRF B-rated scientist, Professor Birkholtz is internationally recognized in the discipline of antimalarial target discovery for sustainable malaria control, reflected in more than 50 manuscripts published within the top 5% of journals in her discipline. She received the University of Pretoria Exceptional Young Academic Achievers award twice before. Her research program trains students in cutting edge approaches to understand complex biological processes, and to apply this to relevant problems of the African continent (malaria). One of her main goals is to enthuse and support a research culture. She assesses the needs of each individual student concerning their personal background and situation, academic prowess and research expertise and subsequently guides and supports the students to reach their academic and personal development goals. She strives to inspire and motivate her students through active guidance, promoting critical thinking, creativity, innovation and intellectual development in all of her postgraduate students.

Laureaattoekennings vir Uitnemendheid in Onderrig 2017
Difoka tša Laureate tša Bokgoni bja Go ruta tša 2017
The Laureates are awarded to nominated projects that display teaching practices with clear purpose and intent, with strong alignment between the different elements in the broader context, that address identified needs or gaps with the aim of innovation to optimise teaching and learning. These nominations show significant evidence of impact on student learning, are sustainable and can be replicated in other contexts. These projects contribute to best practice in teaching and display significant evidence of innovation that addresses the identified challenges.
Die Laureaattoekennings word gemaak aan genomineerde projekte wat bewys lewer van onderrigpraktyke met duidelike doelwitte en goeie belyning tussen die verskillende elemente in die breër konteks, wat spesifieke behoeftes of gapings aanspreek en innovasie ten doel het om onderrig en leer te optimaliseer. Hierdie nominasies lewer betekenisvolle bewys van impak op studenteleer, is volhoubaar en kan in ander kontekste herhaal word. Die projekte dra by tot beste praktyk in onderrig en toon innovasie wat geïdentifiseerde uitdagings aanspreek.
Ba Laureates ba abetšwe go kgetho ya diprotšeke tšeo di bontšhago ditirišo tša go ruta ka maikemišetšo ao a bonagalago le go ikemišetša, ka peakanyo ya go tia gare ga dikokwane tša go fapana ditikologong ka bophara, tšeo di šoganago le dinyakwa tše di lemogilwego goba dikgoba ka maikemišetšo a botšo a go kaonafatša go ruta le go ithuta. Dikgetho tše di bontšha bohlatse bjo bohlokwa bja khuetšo mo go ithuteng ga baithuti, e a thekgwa gomme e ka dirišwa ditikologong tše dingwe. Protšeke tše di kgatha tema go tirišo ye botse ya go ruta gomme di bontšha bohlatsebjo bohlokwa go botšo bjo šoganago le ditlhotlo tše di lemogilwego.

Dr Vandeyar is a senior lecturer in the Department of Science, Mathematics and Technology Education in the Faculty of Education. His main areas of research are best practice in information and communication technologies (ICT) education, which includes teacher professionalism, diversity in education in terms of equity and access to ICT, as well as ICT education policy studies.
Dr Vandeyar argues that an ICT pedagogy is the principal construct in teaching and learning. Thus, the complex nature of pedagogy should not be viewed as being synonymous with teaching, which is regarded as the simple act of transmission of information. This notion of pedagogy is viewed as integral to both teaching and learning, where teaching is intrinsically linked to learning and vice versa. Thus, his teaching practice focusses mainly on shifting the use of ICT merely as a tool to deliver content, to the development of a pedagogy of teaching with technology. The main focus of his practice has been on exposing pre-service teachers to the use of cutting-edge technology as an enabler for developing their pedagogical skills. His passion to advance this pedagogy is informed by his research on teachers’ experiences in ICT-induced classroom practices. To this end he has sought various innovative ways to lead by personal teaching practice, believing that ‘teachers teach the way they are taught’.
Dr Vandeyar’s teaching practice attempts to develop pre-service teachers as agents of change in the use of ICT. His teaching focusses on relevant issues that are accompanied by the use of ICT within and beyond the classroom practices of teachers and also includes enhancing teachers as life-long learners through being members of professional communities of practice.
Numerous innovative practices define his teaching. He uses open source software and open education resources that promote good teaching practices even in resource constrained schools. He also uses ICT as cognitive tools (simulations), constructive tools (augmented reality and concept maps) and instructional tools (tutorials). The creation of interactive concept maps and augmented reality lessons promotes exciting and meaningful pedagogical experiences. Pre-service teachers are exposed to various types of software, their design features and how they fit into the teaching context to enhance learning. Dr Vandeyar’s use of cloud-based learning management systems, mobile technology for formative assessments and classroom management enhances blended learning pedagogical practices. His flipped classroom teaching innovation simultaneously enhances both blended teaching practices and students’ pedagogical practices. Various lessons are delivered parallel to his contact lessons using ClickUP as a platform. He has developed a host of personal flipped-class lessons that incorporates videos, resources and mobile compatible assessments. Incorporating Google collaborative tools into his teaching promotes a blended learning environment. Collaborative tools are used to create cloud-based lessons with embedded multimedia, WWW links and assessments. His teaching practice embodies 21st century learning paradigms of Generativism (the use of educational software to create and design teaching and learning materials) and Connectivism (fosters access to networks and nodes to online resources). Dr Vandeyar uses SwivlTM technology as an active reflective practice. This experience translates into students’ use of educational blogs to reflect on their teaching practices.
Dr Vandeyar has been an invited guest speaker at various international and national institutions. He was the recipient of the Dean’s Award in the Faculty of Education in 2012.

Professor Crole is a veterinarian and associate professor in the Department of Anatomy and Physiology in the Faculty of Veterinary Science where she teaches Veterinary Comparative Anatomy and Veterinary Histology to undergraduate and postgraduate students. Her research focus is on comparative macro-anatomy, histology and electron microscopy of ratites and Southern African wildlife species. She is a council member of the Anatomical Society of Southern Africa and an active member of the Microscopy Society of Southern Africa. Professor Crole is passionate about student learning, understanding and success and fully embraces hybrid teaching to make her subject applicable and available to students from all backgrounds. In addition to her veterinary and research qualifications she also holds a Postgraduate Certificate in Higher Education.
Veterinary Histology requires an entirely different set of learning skills to those with which any of the undergraduate veterinary students are familiar. Histology requires the student to critically evaluate a three-dimensional structure in two dimensions, in strange colours and all the while interpreting artefacts and different planes of sectioning. Add to this the additional complication and resulting intimidation of having to use a microscope and the subject often becomes more work for the students than they believe it to be worth. This results in numerous failures. Professor Crole’s innovations address the problem of how to make Histology engaging and at the same time allows the subject to be presented in a fully hybrid manner. Innovations include flashcards, worksheets, virtual microscopy, recorded lectures and histology practicals, extensive use of ClickUP and talks and demonstrations sponsored and delivered by invited industry partners. Virtual microscopy allows the subject to be mastered by students who do not have regular access to campus. Furthermore, her teaching innovations have made Histology tangible, fun and interactive for group learning and have resulted in increased student success. Some of Professor Crole’s research into her teaching materials has been presented at education conferences and symposia, both locally and overseas. Her international collaborations were fundamental in acquiring virtual microscopy at no cost to UP and which has been used for the first time for teaching Veterinary Histology in South Africa. She is an active participant in the teaching and learning community at the Faculty of Veterinary Science and remains committed to education innovation and the development of educational products and media.
Professor Crole received a Y1 rating from the NRF in 2016. She has received 15 teaching and research awards over a period of ten years. In the past three years these have included the UP Exceptional Young Researcher Award, the Faculty of Veterinary Science Teaching Excellence Award, an award from the Microscopy Society of South Africa conference for the Best Life Sciences Paper Published in an International Journal and awards from the anatomical society conferences for Best Poster and Best Medical Education presentations. Previous awards also include Young Lecturer of the Year, Young Researcher of the Year and a Certificate for Education Innovation.

Toekenning vir Gemeenskapsbetrokkenheid
Sefoka sa Tlemagano ya Setšhaba
The Community Engagement Award is awarded annually to one individual to recognise community engagement as a long-standing and valued tradition in higher education and an extensive, high-impact practice in teaching at the University of Pretoria. The criteria for the award are aligned to those for the MacJannet Award, which is administered by the international Talloires Network. The Vice-Chancellor and Principal, Professor Cheryl de la Rey, is vice-chairperson of the Talloires Network executive committee.
Die Toekenning vir Gemeenskapsbetrokkenheid, wat jaarliks aan een persoon toegeken word, gee erkenning aan gemeenskapsbetrokkenheid as ’n ou en gewaardeerde tradisie in hoër onderwys en ’n uitgebreide, hoë-impakpraktyk in onderrig by die Universiteit van Pretoria. Die kriteria vir die toekenning is in lyn met dié vir die MacJannet-toekenning, wat deur die internasionale Talloires-netwerk geadministreer word. Die Visekanselier en Rektor, professor Cheryl de la Rey, is ondervoorsitter van die uitvoerende komitee van dié netwerk.
Sefoka sa Tlemagano ya Setšhaba se tla abelwa motho o motee ngwaga ka ngwaga go leboga tlemagano ya setšhaba bjalo ka setlwaedi sa lebaka le letelele le seose nago le mohola ka thutong ya godimo le mokgwa wa khuetšo ya godimo, ye e nabilego ka ga go ruta Yunibesithi ya Pretoria. Mabaka a sefoka a amantšhwa le a Sefoka sa Jannet, seo se sepetšwago ke Talloires Network. Motlatšamokhanseliri le Hlogo, Profesa Cheryl de la Rey wa UP, ke motlatšamodulasetulo wa la komitiphethiši ya Talloires Network.

Dr Rautenbach is a senior lecturer in the Department of Geography, Geoinformatics and Meteorology in the Faculty of Natural and Agricultural Sciences. Dr Rautenbach’s research interest is spatial data visualization to support decision-making with a particular interest in informal settlements.
The geoinformatics degrees at the University of Pretoria are accredited by the South African Geomatics Council (SAGC). The Council requires students to acquire certain geographic information science (GISc) knowledge and skills, but they should also develop soft skills needed as GISc professionals. Dr Rautenbach is the course coordinator and lecturer for the final-year geoinformatics project. The aim of the module is to provide students with the opportunity to complete a project from start to finish in which one or more of the studied techniques of data acquisition and processing are used to produce an output of geographically referenced information. To facilitate this, we rely on a community-based service learning approach in an informal settlement called Alaska in the east of Mamelodi, City of Tshwane.
The University has a longstanding partnership with the Viva Foundation that facilitates various outreach and development projects in the settlement, such as early childhood development and enhancing the safety of women. In 2015, when GISc researchers first visited the informal settlement of Alaska, they had no information about the structure of the settlement, such as the location of tuck shops or communal taps. This information is invaluable to the Viva Foundation to plan impactful interventions in the settlement. For their final year project, the students map an informal settlement and implement a web solution for a problem that they identified in the community. This approach takes them through the entire project lifecycle from data acquisition to presentation of their final results in an easy to understand format, while at the same time giving them the opportunity to put to practice GISc knowledge and skills acquired in individual modules. This allows for a more interactive class environment. Students work in teams which create a social learning space for the acquisition of soft skills, such as teamwork, communication, time management and emotional intelligence. This provides the students with a glimpse into the working environment and on how to resolve conflicts within the group to ensure that a successful end product is delivered. Students experience a great sense of accomplishment on completion of the module, not only through their involvement in mapping the informal settlement but also by being able to give back through activities with the children at the local school, such as a map competition.
Over the last two years, with the projects based on a community service learning approach, two projects have won awards and two other projects were selected as finalists. In 2016 a student won the Esri Young Scholar award for her project entitled, A GIS-based response time and risk analysis of municipal firefighting services in the Alaska informal settlement and team Apex PentaVertex won the Responsive Cities Challenge for their prototype, VivaImpilo, which is a web-based business intelligence warning system aimed at providing relevant information to the communities of Ekurhuleni.
Although the Community Engagement award is for an individual, it would have been impossible without the support of colleagues, the dedication of the students, the welcoming community of Alaska and Viva Foundation.

2018 NNS-gegradeerde Navorsers
Banyakišiši ba 2018 bao ba lekaneditšwego ke Motheo wa Dinyakišišo wa Setšhaba



Professor Meyer was appointed at the University of Pretoria as professor and Head of Mechanical and Aeronautical Engineering in 2002 and as Chair of the School of Engineering in 2004.
He leads the Clean Energy Research Group which he established with a broad focus on thermal sciences and fluid flow, and a narrower focus on heat exchangers. His heat exchanger work focusses on fundamental work of flow in the transitional flow regime, nanofluids, and condensation. On an applications level his work focusses on thermal, solar, wind and nuclear energy.
Professor Meyer has received five national teaching awards from three different universities, as well as an international award. He has won more than 20 awards for best article of the year or best conference paper. For his research he has won the following national and international awards: the Thomas Price Award, the Rand Coal Award, the LT Campbell-Pitt Award, the Literati Award, and the Will Stoecker Award. He is a member or Fellow of various professional institutes and societies such as ASME, ASHRAE, AIAA, and the Royal Aeronautical Society.
He is on the editorial board of 13 journals and is or was the editor of seven journals. He has (co)authored more than 800 articles, conference papers, and book chapters, and has (co)supervised more than 100 research masters and PhD students. In 2016 he received the Exceptional Supervisor Award from the University of Pretoria. This is his sixth exceptional achiever award from the University of Pretoria.
He received an A2 rating from the NRF.

Professor Millar has been a faculty member at UP since 2011 and is the Director of the Centre for Reproductive Neuroendocrinology at the University of Pretoria. He is also a Senior Research Fellow at the University of Cape Town, Research Fellow at the University of Edinburgh and emeritus professor at the University of St Andrews. From 1998 to 2011 he was director of the UK Medical Research Council's prestigious Human Reproductive Sciences Unit at the University of Edinburgh.
He has published over 450 papers in peer-reviewed journals and holds 18 patents. He has an h-index of 79 and his work has been cited more than 23 000 times. He serves as the editor-in-chief of the prestigious international journal, Neuroendocrinology, and was elected president of the International Neuroendocrinology Federation (INF) in 2016.
Among other awards Professor Millar has received the Wellcome gold medal, the Oppenheimer gold medal, the Geoffrey Harris Award of the International Neuroendocrine Federation, the Ernst and Berta Scharrer Prize of the International Society of Comparative Endocrinology, the John F Herschell gold medal which is the highest award of the Royal Society of South Africa, the Harry Oppenheimer Fellowship (R1.5 million) and the platinum medal of the Medical Research Council for lifetime achievements in medical research. He received the lifetime achievement award of the Society for Endocrinology and Diabetes of South Africa and the African Union Kwame Nkrumah Continental Award for Scientific Excellence ($100,000) in 2018. He is a Fellow of the Royal Society Edinburgh, Fellow of the Royal Society South Africa, member of the Academy of Science of South Africa and Fellow of the Royal Society of Pathologists.
He has made seminal and pioneering discoveries of novel hormones and receptors in neuroendocrinology which have transformed the field. His most recent research focusses on the breakthrough discovery that function can be restored to inactivating mutations in human G-protein-coupled receptors which are responsible for most cell communication. This discovery unlocks the possibility for precision and personalised therapeutics with the potential to treat a variety of diseases including blindness, obesity, diabetes, and thyroid, muscle, kidney, reproductive and mental health conditions.
Professor Millar received an A2 rating from the NRF in 2018 and has been rated as an A scientist four times in the past.
Professor Bradlow is SARCHI Professor of International Development Law and African Economic Relations at the University of Pretoria and professor emeritus at the American University Washington College of Law in Washington, DC. He was previously the first head of the International Economic Relations and Policy Department at the South African Reserve Bank, and professor of law and director of the International Legal Studies Program at American University Washington College of Law in Washington, DC. He has also served as the chair of the Roster of Experts for the Independent Review Mechanism at the African Development Bank; an expert member of the African Commission on Human and People’s Rights Working Group on Extractive Industries, the Environment and Human Rights; co- rapporteur, International Law Association Study Group on Responsibility of International Organizations; a member of the Board of Directors of New Rules for Global Finance, the executive council of the American Society of International Law, the advisory boards of the Financial Regulation and Human Rights Project; Law, Social Justice and Global Development Journal; the American University International Law Review and Sustainable Development Law and Policy.
He was previously a member of the High Level Panel on the Governance of the Financial Stability Board, an advisor to the Global Initiative on Fiscal Transparency, a Senior Special Fellow in the Legal Aspects of Debt and Financial Management Programme of the United National Institute on Training and Research (UNITAR), and a consultant to numerous international organizations including the World Bank, World Commission on Dams, the Commonwealth Secretariat and the European Bank for Reconstruction and Development and a member of the International Law Association’s Committee on Accountability of International Organizations. He has published numerous books and articles on topics that include public international law, the international law applicable to international financial institutions, foreign direct investment law, reform of international financial institutions, global economic governance and the legal issues arising from large projects.
Professor Bradlow received a B1 rating from the NRF.
Professor Chen is extraordinary professor in the Department of Statistics, Faculty of Natural and Agricultural Sciences. Professor Chen is internationally known for his research in biostatistics and has been responsible for more than 200 peer-reviewed publications and 23 books in biostatistics. He is a world leader in biostatistics research, especially in the design and analysis of clinical trials, Bayesian biostatistics, causal inference and structural equation modelling, survival data analysis, biostatistical meta-analysis and mega-analysis, Monte-Carlo simulations and advanced statistical computations. As such, he has become an international leader on methodological development for South Africa’s international collaborations in biostatistical research.
Due to his significant contributions, including his leadership and prominent research in biostatistical methodology, his excellence in teaching and mentoring, and prodigious and significant service to the profession, Professor Chen was honoured as an elected Fellow of the American Statistical Association (ASA) and an elected member of the international Statistical Institute (ISI) in 2016. In addition, in 2017, Professor Chen was awarded the first Tier 1 SARChI Chair in Biostatistics funded by the South Africa Department of Science and Technology (DST), the National Research Foundation (NRF) and the South African Medical Research Council (SAMRC).
Professor Chen received a B2 rating from the NRF.
Professor Coutinho is a professor in the Department of Biochemistry, Genetics and Microbiology, Faculty of Natural and Agricultural Sciences. Her research focus is on pathogenic bacteria and their interaction with plant hosts. She initially focussed her research on the causal agent of bacterial blight and die-back of Eucalyptus. This study led to the description of numerous new bacterial species, many of which are considered ‘ unusual’ due to their opportunistic nature. Improved understanding of how they cause disease symptoms led to the sequencing of the first plant pathogen genome in Africa. Comparative and functional genomics illustrated how this ubiquitous bacterium was able to survive in unusual niches in the environment, as well as in insect and human hosts, and how they infect plants. She has subsequently expanded her programme to include plant pathogenic bacteria of fruit trees and vegetable crops.
Over the past 15 years since she initiated her research programme in phytobacteriology Professor Coutinho has supervised 22 MSc and eight PhD students in the field. She has an h-index of 37 (Scopus) and 45 (Google Scholar) with 3924 and 6233 citations respectively. She has featured in the Thomson Reuters Science Indicators list of the top 5 000 most cited scientists in the plant sciences for the past 20 years. She is the past president of the Southern African Society for Plant Pathology (SASPP) and is actively involved in the American Society of Microbiology (ASM) as their South African ambassador. In 2013 and 2016 she received the Exceptional Academic Achievers award from the University of Pretoria.
Professor Coutinho received a B2 rating from the NRF.




Professor Ewing is an extraordinary professor in the Faculty of Economic and Management Sciences. He is currently Executive Dean of the Faculty of Business and Law and Vice President at Deakin University, Australia. He is also an Alfred Deakin Distinguished Professor.
Professor Ewing’s research interests include marketing communications, brand management, and health promotion. He has published over 120 articles in refereed journals, including the Journal of the Academy of Marketing Science, Information Systems Research, the International Journal of Research in Marketing, Social Science & Medicine, the Journal of Service Research, the Journal of Advertising Research, the Journal of Advertising, Industrial Marketing Management, Psychology & Marketing and the European Journal of Marketing. Three meta-analyses rank him the most productive marketing communications researcher worldwide. In 2010 he was made a Distinguished Fellow of the Australia New Zealand Marketing Academy and appointed to the inaugural advisory board of the Academy of Indian Marketing. Professor Ewing was recognised as a distinguished Fellow of the Academy of Marketing Science in May 2012 and the Australian Marketing Institute in December 2017. He is currently vice-president of the Australian Business Dean’s Council. His h-index is 46 and he has more than 7,600 citations.
Prior to entering full time academe, Professor Ewing was the marketing research manager for Ford Motor Company’s South African subsidiary (SAMCOR). He is an alumnus of the University of Pretoria (doctorate, master’s and honours) and the University of Natal.
Professor Ewing received a B1 rating from the NRF.

Professor Focke is a professor in the Department of Chemical Engineering and Director of the Institute of Applied Materials. His research in the field of materials science and engineering covers various topics.
His research on carbon technology focusses on the use of expandable graphite in thermal energy applications and as conductive and flame-retardant additive in polymer. A highlight in this research was the development of an elegant method for making mediumdensity graphite foams with high thermal conductivity. The clay and polymer additive technology research is targeted towards functional applications in polymers in order to improve thermo-oxidative stability and flame retardancy.
In the field of pyrotechnics, he successfully developed a range of ‘green’ compositions for use as time delays and initiating compositions in chemical mine detonators.
His achievements in respect of malaria vector control relate to the controlled delivery of the following repellents and insecticides:
• A particle-stabilised insecticide for indoor residual spray that outlasted DDT in laboratory trials
• A patented low-cost wall lining that has just successfully completed a five-year field trial in the Limpopo province
• Mosquito-repellent textiles based on bicomponent fibres that are currently in an industrial scale-up trial phase
• A particularly effective topical mosquito repellent blend that also kills insects.
Professor Focke received a B3 rating from the NRF.

Professor Frick is an extraordinary professor in the Department of Mathematics and Applied Mathematics in the Faculty of Natural and Agricultural Sciences, where she is currently supervising a postdoctoral student. Her research area is graph theory.
In the past three years she has had eight joint publications with various international research groups and hosted three graph theory workshops in Salt Rock, KZN. The workshop participants included local collaborators, and internationally esteemed graph theorists from Germany, Canada and the USA, including the Danish researcher, Carsten Thomassen, who is internationally recognised as a world leader in graph theory and with whom she has a fruitful ongoing collaboration. At the request of the editors she also wrote a chapter for the book Graph Theory, Favorite Conjectures and Open Problems - 2. In 2015 she was invited (and sponsored by the hosts) to participate in a C5 International Graph Theory Workshop in Rathen, Germany and a focused workshop at the Banff International Research Station for Mathematical Innovation and Discovery in Canada.
Professor Frick received a B2 rating from the NRF.
Professor Joubert received the BEng, MEng and a PhD in Electronic Engineering from the University of Pretoria in 1983, 1987 and 1991 respectively. In 1988 he joined the Department of Electrical, Electronic and Computer Engineering where he is currently professor and Head of Department. He has spent time as visiting scientist at various international institutions, such as California State University in the USA, Industrial Research Laboratories in New Zealand, the University of Karlsruhe in Germany, and Loughborough University in the UK. His research interests include antenna array design and computational electromagnetism.
In 2000 he received a Mellon Foundation Award with PhD student Philip Niemand. He was awarded an Erasmus Mundus Scholarship from the MERIT consortium in 2006 for research at the University of Karlsruhe, Germany. He was recognized as Exceptional Academic Achiever by the University of Pretoria in 1999, 2002, 2005, 2008 and 2013.
Publications to date include one book chapter, 91 papers in peer-reviewed journals and 68 papers presented at conferences. He has successfully supervised or co-supervised 20 MEng students and 11 PhD students.
Professor Joubert is a registered professional engineer in South Africa, a senior member of the Institute of Electrical and Electronics Engineers (IEEE), and a Fellow of the SA Academy of Engineering.
Professor Joubert received the B3 rating from the NRF.
Professor Kirberger is an extraordinary lecturer in the Department of Companion Animal Clinical Studies in the Faculty of Veterinary Science.
He is a professor of veterinary diagnostic imaging and has been employed by the University for the past 30 years. In the first 14 years of this century he spent most of his research time on a nematode called Spirocerca lupi which causes oesophageal masses that undergo neoplastic transformation in dogs. He received a DVSc degree for this work in 2013. His small animal research currently involves the benefits of computed tomography in traumatised dogs. Another research interest he is passionate about is diagnostic imaging of large felids, and in particular that of the endangered cheetah. His research on normal diagnostic ultrasound parameters in cheetahs has enhanced the capabilities of wildlife veterinarians to treat sick cheetahs under field conditions, thus improving their chances of survival. Professor Kirberger has 110 peer-reviewed articles to his name, and is the senior editor of the 2016 BSAVA Manual of Canine and Feline Musculoskeletal Imaging and the president of the International Veterinary Radiology Association.
Professor Kirberger received a B2 rating from the NRF.
Professor Limebeer is an extraordinary professor in the Department of Electric, Electronic and Computer Engineering. In 1974 he received the BSc(Eng) degree from the University of the Witwatersrand, and the MSc(Eng) and PhD degrees from the University of Natal in 1977 and 1980, respectively, with a DSc(Eng) from the University of London in 1992. After completing his PhD deree he was a postdoctoral researcher at the University of Cambridge from 1980 to 1984. He then joined the Electrical and Electronic Engineering Department at Imperial College as a lecturer. He was promoted to Reader in 1989, Professor in 1993, Head of the Control Group in 1996, and Head of Department for the period 1999 to 2009.
In 2009 he moved to Oxford as Professor of Control Engineering and Professorial Fellow at New College Oxford. His research interests include a range of applied and theoretical problems in control systems and engineering dynamics, including robust control, optimal control, vehicular control, process control and the control of aeroelastic phenomena in large structures. He is also interested in a variety of problems in multibody mechanics and two- and four-wheeled vehicle dynamics. He is a Fellow of the IEEE (1992) (for contributions to multivariable systems theory), a Fellow of the Royal Academy of Engineering (1997), a Fellow of the Institute of Electrical Engineers (1994), and a Fellow of the London City and Guilds Institute (for outstanding professional and personal achievement). His has consulted on a variety of vehicle-related matters, product liability litigation, and patent disputes in optical recording systems, drilling equipment and high-speed packing machines.
Professor Limebeer received a B1 rating from the NRF.




Professor Maluleke is a respected academic and public intellectual. A theologian by training, he is currently Advisor to the Vice-Chancellor and Principal of the University of Pretoria. His research interests and expertise are trans- and inter-disciplinary and therefore extend well beyond the discipline in which he obtained his doctorate. Professor Maluleke is well read in the humanities and social sciences and has published more than 90 papers in peer-reviewed journals and books, as well as dozens of opinion pieces on critical social, political and religious issues of our time. He has supervised 11 PhD students to completion.
Professor Maluleke is a member of the Academy of Science of South Africa (ASSAf) and a member of the NRF Board, as well as a board member of Khulumani NGO.
He has been a visiting professor and guest lecturer at several universities, including Hamburg University (Germany), Johannes Gutenberg University (Germany), the University of Nairobi (Kenya), the University of Botswana, the University of Vienna (Austria), Duke University (USA), Haverford College (USA), Lund University (Sweden), the University of Lausanne (Switzerland) and the University of Swaziland.
He has held several executive management positions at various South African universities, including that of deputy executive dean, dean, executive director: research, deputy registrar and deputy vice- chancellor. Prof Maluleke is a columnist for the Mail & Guardian and Sunday Independent newspapers.
Professor Maluleke received a B1 rating from the NRF.

Professor Myburg is a professor in Genetics in the Faculty of Natural and Agricultural Sciences. He is the Director of the Forest Molecular Genetics (FMG) Programme of the Forestry and Agricultural Biotechnology Institute (FABI) and he holds the Chair in Forest Genomics and Biotechnology at the University of Pretoria. His research team pioneered the use of population genomics and systems genetics approaches to unravel the genetic control of growth and wood formation in Eucalyptus trees. He was the lead investigator of the international Eucalyptus Genome Project, aimed at unravelling the genetic blueprint of this genus of woody plants that includes some of the fastest-growing wood fibre crops on earth. This information is being used to develop biotechnology applications for tree improvement in South Africa, including DNA fingerprinting, genome-assisted breeding, genetic engineering and genome editing to facilitate production of pulp, paper, timber, biorefinery and other bioeconomy products. He has supervised 58 postgraduate candidates (MSc, PhD and postdoctoral) and is the author of 91 ISI peer-reviewed papers and book chapters in the field of plant molecular genetics and genomics. In 2015 he received the TW Kambule Award at the NSTF-BHP Billiton Awards for his contribution to research and its outcomes in South Africa over the last five to ten years.
Professor Myburg has a B1 rating from the NRF.

Professor Nel is professor in the Department of Microbiology and Plant Pathology, Faculty of Natural and Agricultural Sciences, where he has established a world-renowned research program focused on a better understanding of the rabies virus and other lyssaviruses with the aim of improving treatment and control of rabies. To date he has published more than 150 papers in scientific journals and books. He is a regular reviewer for leading international journals (more than 25 titles).
He is a permanent member of the World Health Organization (WHO) expert advisory panel on rabies and a member of the international steering committee of the Bill and Melinda Gates Foundation/World Health Organization (BMGF/WHO) rabies control programmes (2009 to date). He has been the scientific advisor and coordinator for the Southern and Eastern African Rabies Group (SEARG) since 2003. With the help of his team at UP and global collaborators, he founded the Pan African Rabies Control Network (PARACON) in 2015. He is an active member of the technical expert panel of the International Atomic Energy Agency and the UN Food and Agriculture Organization (IAEA/FAO). Since 2008 he has assisted the Global Alliance for Rabies Control (GARC) in various capacities and in 2014 he took over the leadership. The Global Framework for the Elimination of Dog-Mediated Human Rabies was developed in 2015 and 2016 and Professor Nel serves on the global steering group.
A recent study found that rabies research increased on a global level by 5.87% per annum between 2006 and 2015. South Africa scored 14th overall in rabies research productivity and was third in the category International Collaborative Publications of the Top Countries. The University of Pretoria is rated among the top 20 Most Productive World Organizations on Rabies Research in the 11th position and third overall among universities. Professor Nel is one of the top 20 most productive individual authors on rabies.
Professor Nel received a B3 rating from the NRF.
Professor Odendaal is professor in the Department of Electrical, Electronic and Computer Engineering in the Faculty of Engineering, Built Environment and Information Technology, and the Director of the Centre for Electromagnetism.
His research focusses on achieving a high level of excellence in electromagnetic technology, particularly in the design, development and evaluation of microwave antennas, radar backscatter and antenna measurements. He has contributed to the development of various high-performance wide-band double- and quad-ridged horn antennas. He also proposed a standard for the ultra wide-band calibration of a complex antenna factor in the compact range, and developed a procedure to improve the accuracy of gain measurements for base-station antennas using a modified gain-transfer method. He has developed sound theoretical foundations for accurate gain measurements and field densities that can be applied to the traceable calibration of microwave field probes.
He is a senior member of both the Institute of Electrical and Electronic Engineers and the South African Institute of Electrical Engineers, and a member of the Antenna Measurement Techniques Association. He has authored and co-authored more than 70 papers published in international peer-reviewed journals, and has presented 58 papers at international conferences.
Professor Odendaal received a B3 rating from the NRF.
Professor Pattinson is the Director of the South African Medical Research Council (SAMRC)/ University of Pretoria Maternal and Infant Health Care Strategies Research Unit and Clinical Head of the Department of Obstetrics and Gynaecology at the University of Pretoria.
He serves on the National Committee for Confidential Enquiries into Maternal Deaths and the National Perinatal Morbidity and Mortality Committee in South Africa, and is responsible for the perinatal care and child health care surveys in South Africa. His main research interests are in obstetrics, medical audits, health systems and effective outreach methods, and his research focusses on determining the most effective way to implement new health care strategies and improve current programmes. Currently his main research efforts are in determining the most efficient ways to scale up emergency obstetric care, detect foetuses at risk of still birth and improve intrapartum care.
Professor Pattinson received a B1 rating from the NRF.
Professor Sango hails from the Ivorian town of Issia. In 1986 he obtained his baccalaureate (matric) from the prestigious high school, the Lycée Technique d’Abidjan, before proceeding to study mathematics in the former Soviet Union. In 1993 he graduated from Donetsk State University in the Ukraine with a master’s degree in physico-mathematical sciences.
In 1998 he obtained his Doctorate in Applied Mathematics at the University of Vallenciennes in France. Professor Sango is currently professor in the Department of Mathematics and Applied Mathematics where he is the research and postgraduate coordinator for mathematical sciences in the Faculty of Natural and Agricultural Sciences.
His research interests are at the crossroads of three major fields, namely partial differential equations, stochastic processes and differential geometry. He has made significant contributions to several problems, notably spectral problems with indefinite weights for general elliptic boundary value problems, the homogenization of deterministic and stochastic partial differential equations, and in some mathematical problems related to turbulent flows of fluids governed by stochastic partial differential equations.
His distinctions include a one-semester visiting position at the Institut des Hautes Études Scientifiques (IHES), France, a Fellowship from the Japan Society for the Promotion of Science, a membership of the School of Mathematics at the Institute for Advanced Study in Princeton, USA, and several visiting positions at Princeton University.
Professor Sango received a B2 rating from the NRF.




Professor Scholtz, an emeritus professor in the Department of Zoology and Entomology in the Faculty of Natural and Agricultural Sciences, is considered a world leader in Scarabaeoidea (dung beetles). However, his research is focused on the biology and conservation of insects in general.
During his long and distinguished academic career, he supervised approximately 60 master’s and doctoral students and published some 200 refereed papers, three textbooks and two children’s books. Most of his research publications and his two most recently published books deal with dung beetles.
He is a member of the American Coleopterists Society, the European Association of Coleopterology, the Entomological Society of Southern Africa, the Zoological Society of Southern Africa and the SA Society for Systematic Biology (SASSB), and a Fellow of the Royal Entomological Society. He has served as president of two professional societies, namely the South African Entomological Society (1992, 1995) and the SASSB (2000).
He has received numerous awards for his research, including the Dozor and Friends of Ben-Gurion Award for Research from the Ben-Gurion University in Israel, the British Council Travel Award and the Overseas Development Agency Visitorship Award. He has received a UP Exceptional Achiever Award every year since its inception, and twice received the Chancellor’s Award for Research Excellence. In 2004 he received the NRF President’s Award for international research leadership, and in 2008 he was recognised by UP as one of the 100 top researchers in the University’s 100-year history.
Professor Scholtz received a B2 rating from the NRF.

Professor Schönfeldt is the Director of the new African Research Universities Alliance (ARUA) Centre of Excellence for Food Security led by the University of Pretoria in collaboration with the University of Nairobi and the University of Ghana, Legon.
Her research focusses on linking nutrient quantity and quality of foods to sustainable food systems for attaining nutrition and food security for all. She continually publishes evidence on why country specific food composition data is essential to make it possible to interpret the dietary outcomes of countries from both an under- and overnutrition perspective.
Professor Schönfeldt serves as scientific advisor to the SA National Department of Health, which includes tasks such as the development of policies, participation in advisory panels and Codex Alimentarius. She serves as scientific advisor to Afrofoods, a network on the African continent, training 164 individual participants from 24 different African countries forming part of IUNS/UNU/FAO INFOODS Task Force. She was the reviewer of the School Feeding Scheme and the Implementation Evaluation of Nutrition Interventions for Children from Conception to Age 5, both established by the Department of Planning, Monitoring and Evaluation.
She has published extensively with more than 120 articles in scientific journals, books, chapters in books and conference proceedings, and has authored more than 170 research reports. Professor Schönfeldt has supervised or co-supervised more than 31 postgraduate MSc and PhD students.
Professor Schönfeldt received a B3 rating from the NRF.

Professor Steyn is an emeritus professor and former head of the Department of New Testament Studies in the Faculty of Theology. He holds two doctorates, one in theology and another in humanities.
His research focusses on the use of the Greek Old Testament (Septuagint: LXX) by the New Testament writers and by Philo of Alexandria (ca 20 BCE to 40 CE). He investigates the possible underlying LXX versions amongst these authors by reconstructing its text forms from the commonalities and differences in comparative analyses between the ancient authors. The data is collected and organised with a view of compiling a threevolume synopsis of Old Testament quotations in the New Testament which compares the textual variants of the two corpuses with each other. The identification of different LXX versions enables us to better understand the interpretation of religious scriptures during Hellenistic times.
In 2017 Professor Steyn hosted the meeting of the prestigious international society STUDIORUM NOVI TESTAMENTI SOCIETAS (membership by invitation only) in Pretoria. In 2015 and 2016 he was the recipient of a Humboldt Research Fellowship for his academic enquiry and he participates in several international specialist research teams in South Africa, Germany and Greece.
Professor Steyn received a B3 rating from the NRF.
Professor Van der Vyver is an extraordinary professor in the Department of Private Law and the IT Cohen Professor of International Law and Human Rights in the School of Law of Emory University in Atlanta, Georgia, in the United States of America.
His academic qualifications include the LLD degree (University of Pretoria), LLD honoris causa (University of Zululand), LLD honoris causa (Potchefstroom University), and the Diploma of the International Institute of Human Rights in Strasbourg, France.
His lecturing assignments include international law, international human rights, international criminal law, humanitarian law, the implementation of international law in the United States, and legality of armed interventions. The current focus of his research is international criminal law. He is currently in the final stages of a three-volume book on the structures of the International Criminal Court (ICC), crimes within the jurisdiction of the ICC, and the functioning of the ICC with reference to concrete cases. In 1976 he introduced the very first course in human rights at a South African university. His book, Die Beskerming van Menseregte in Suid-Afrika was awarded the Toon van den Heever Prize in 1978.
Professor Van der Vyver received a B3 rating from the NRF.
Professor Vinck is a professor in the Department of Speech-Language Pathology and Audiology. From 2011 to 2017 he was Head of Department and full-time chair of the Applied Social Sciences disciplinary cluster in the Faculty of Humanities. On 1 October 2017 his appointment changed to a part-time position as professor at the University and Director of the UP Cochlear Implant Unit (CIU). In addition he is currently working as part-time Head of Department of the Department Speech-Language and Hearing Sciences at Ghent University in Belgium.
Professor Vinck has extensive clinical and research experience in the fields of clinical audiology, cochlear implants, tinnitus and vestibular testing. He is (co)author of more than a 100 high impact international publications in the field of noise-induced hearing loss, tinnitus, vestibular electrophysiology and cochlear implants. He is very active as supervisor of international postgraduate students, both at master’s and at PhD level and is well-known for lecturing across the world.
He recently received a prestigious NRF-NEP grant, bringing the first electronic rotary chair for advanced vestibular testing (used in medical testing and space research, among others) to the University of Pretoria and to the African continent.
Professor Vinck has a B3 rating from the NRF.


Professor West-Pavlov is a research associate in the Department of English in the Faculty of Humanities at the University of Pretoria (UP) and a professor of English at the University of Tübingen, Germany.
His research focusses on Australian, Caribbean and African literary and cultural studies. He has written numerous articles on South African literature produced post 1994, and a book titled Eastern African Literatures: Towards an Aesthetics of Proximity, which was published by Oxford University Press in 2018. His interest in cross-regional and trans-disciplinary issues was fuelled in particular by a large-scale DAAD-funded network project that involves universities in Africa, Latin America and Australasia, and has led to the publication of a first-ever edited compendium of essays on the emergent concept of the Global South, titled The Global South and Literature (Cambridge University Press, 2018). A recent cross-generic collaboration with the Australian poet John Kinsella at the nexus of poetry, autobiography, essay and photography has resulted in the co-authored : On the imperatives of place (Narr-Franke-Attempto, 2018).
tεmp( )r rIn s e e e
Professor West-Pavlov received a B2 rating from the NRF.


Professor Abolnik is a virologist and microbiologist who specialises in poultry diseases. At the beginning of the year she was awarded the new NRF SARChI Chair in Poultry Health and Production, the first SARChI Chair to be awarded to the Faculty of Veterinary Science.
In August 2012 she joined the Department of Production Animal Studies as the Research Chair in Poultry Health and Production, an initiative funded by the South African Poultry Association to drive critical research into diseases that affect the industry. She is recognised internationally as the sub-regional expert on avian influenza and Newcastle disease. She has published more than 55 papers on avian influenza, Newcastle disease, infectious bronchitis, and mycoplasmosis across the disciplines of epidemiology, ecology, evolutionary dynamics, genomics, and molecular and serological diagnostic test development in conjunction with her research group and through international collaboration. In 2016 she received the African Union Kwame Nkrumah Award for Scientific Excellence (AUKNASE).

Dr Aluko, a researcher and instructional design supporter in the Unit for Distance Education in the Faculty of Education, manages the quality assurance of distance education practices in the Unit.
Working in the field of Distance Education (Open Distance Learning), her areas of research are quality assurance and management, access, social justice, inclusion and exclusion, mobile learning and technologies, programme evaluation, impact studies, student support and distance learning transfer.
She holds a BEd(Hons) (Adult Education, Communication and Language Arts) and an MEd (Adult Education) from the University of Ibadan, Nigeria, and a PhD (Curriculum and Instructional Design Development) from the University of Pretoria.
She has been involved in the institutional evaluation of Open Distance Learning (ODL) programmes and is a co-editor of the book Assuring institutional quality in Open Distance Learning (ODL) in the developing contexts (2016), published by Nova Publishers, USA. She currently serves on the editorial board of Africa Education Review, and is an executive member of the National Association of Distance Education in Southern Africa (NADEOSA). Dr Aluko co-organises the biennial conference on Distance Education and Teacher Training, which brings together distance-education practitioners from Africa and beyond.
Dr Aluko received a C3 rating from the NRF.

Professor Annandale is a professor in the Department of Plant and Soil Sciences in the Faculty of Natural and Agricultural Sciences. He is an applied agricultural scientist, with a focus on improving water and solute management in irrigated crop production, in order to increase efficiency of production and to reduce environmental impact. He has recently led a Water Research Commission (WRC) project on the updating and improvement of the national Irrigation Water Quality Guidelines. This involved the development of a computer model based Decision Support System (DSS) that determines multi-tier, risk based, site-specific water quality guidelines, of critical importance to both irrigators and regulators of our water resources. In addition, he has also resumed his research on the use of mine water for irrigation, a practice that, if carried out responsibly, can save billions of Rand in alternative water treatment costs. His contribution to irrigation water management was recently recognised through a WRC Knowledge Tree Award for New Products and Services for Economic Development, which is ‘awarded to projects that have contributed to job creation and economic development through the development of innovative technologies’.
He received a C2 rating from the NRF.
Professor Barnard is an associate professor in the Department of Mercantile Law, Faculty of Law, and holds the degrees LLB (Pret), LLM (Unisa) and LLD (Pret).
In 2002 she was admitted as attorney of the High Court of South Africa. She joined the Department of Mercantile Law at the University of Pretoria in 2008 on a full-time basis and completed her doctoral thesis titled The influence of the Consumer Protection Act 68 of 2008 on the common law of sale in 2013.
She specialises in and teaches law pertaining to specific contracts (sale, lease, agency and surety), as well as consumer protection law (national and international) at undergraduate and postgraduate level. Professor Barnard is the co-author of a leading book in consumer law, Consumer Protection Law in South Africa, second edition (2018). She has published many accredited publications in national and international journals and contributes to the in-house journal, Regulatory Debates, of the Department of Trade and Industry. Professor Barnard is also part of the organising committee of the University of Pretoria International Consumer Law Conference (UPICLC), the first of its kind in South Africa which has been taking place bi-annually since 2014.
Professor Barnard received a C2 rating from the NRF.
Professor Bester is a professor in, and Head of the Section: Cell Biology, Histology and Embryology in the Department of Anatomy, Faculty of Health Sciences.
Her research focusses on the use of cell models to evaluate cellular effects, specifically the antioxidant, anti-inflammatory, anticancer and anti-diabetic effects of functional foods, nutraceutical products, medicinal plants and novel multifunctional peptides. Collaborative studies have identified indigenous, functional African foods, such as leafy green vegetables, teas, honey, indigenous plants and grains and legumes that may have beneficial effects and might prevent oxidative and inflammatory damage, and possibly associated diseases. Cell-based studies have also identified the beneficial bioactive effects of novel antimicrobial peptides. In the past ten years, successful collaborations established within the Department and with the Departments of Biochemistry and Food Sciences have led to 35 publications in peer-reviewed journals and the successful supervision of 43 postgraduate MSc and PhD students. At the pre-graduate level, she is responsible for teaching histology to medical and dental students, and cell and tissue techniques and developmental biology to science students. She is a member of the Research Ethics Committee of the University of Pretoria and of several subject-related organisations.
Professor Bester received a C3 rating from the NRF.
Professor Beyers is an associate professor in the Department of Science of Religion and Missiology in the Faculty of Theology, and manager of the Religious Studies programme.
His research is focused mainly on the presence of secularisation in an African context. The study of religion in Africa contributes to our understanding of the nature and function of religion. Closely related to this is research that focusses on the formulation of a theology of religions, which contributes to and determines relationships in interreligious dialogue. Since religion is not limited to doctrine and texts, but also finds expression in empirical forms such as art, he also studies religious expressions in art in Africa as a form of material religion.
During the past three years, awards made available by the Erasmus Mundus programme have enabled him to accept invitations to visit the University of Vienna, Austria, and the University of Porto, Portugal, as a guest lecturer.
Professor Beyers received a C3 rating from the NRF.




Professor Bosman is an associate professor in the Department of Afrikaans, where she teaches Afrikaans linguistics at undergraduate level and linguistics and applied linguistics at honours level. Her research interests include two subfields, namely cognitive semantics and sociolinguistics.
Metaphor research has dominated cognitive semantics since the seminal work by Lakoff and Johnson, Metaphors we live by. Professor Bosman is currently investigating metaphors of eating and drinking in Afrikaans in a series of articles by doing corpus-based research. Together with Professor Elsabé Taljard, she investigated cross-cultural metaphors in Afrikaans and Northern-Sotho. Her article ‘EET en DRINK in Afrikaans — ’n leksikaal–semantiese ondersoek’ received two prestigious prizes in 2017: the ATKV-SA Akademieprys, as well as the Esther Greeff prize from the SA Akademie vir Wetenskap en Kuns.
In 2014 she received an NRF grant for a research project, ‘An investigation into the Afrikaans system of address’. Pronouns, names, titles and address forms reveal not only the kind of relationship that exists between two interlocutors, but also changing socio-economic realities. Professor Bosman is currently writing up the results of the field work she has undertaken in a scholarly book.
Professor Bosman received a C3 rating from the NRF.

Professor Botha, an associate professor and researcher in the Department of Business Management, Faculty of Economic and Management Sciences, is the programme lead for the MPhil in Entrepreneurship.
Working in the field of Entrepreneurship, she started her career by concentrating on the empowerment of women entrepreneurs in South Africa and developed the Women Entrepreneurship Programme (WEP). Her research focusses on training, educating and supporting entrepreneurs at different stages of preparing, starting and managing a business.
She holds a BCom in Tourism Management (cum laude), an MPhil in Entrepreneurship (cum laude) and a DCom in Business Management from the University of Pretoria. Professor Botha received the Anton Rupert Prize for the best research thesis for a DCom in business management.
She is a member of the South African Institute for Management Sciences (SAIMS) and the Africa Academy of Management (AFAM), as well as an external reviewer for national and international entrepreneurship and management journals. She has made numerous presentations to entrepreneurial and public sector organisations on women entrepreneurship and skills for the training of entrepreneurs. She has produced research articles and conference papers and was awarded the prize for best researcher by the Department of Business Management in 2006, 2010 and 2017.
Professor Botha received a C3 rating from the NRF.

Professor Botha is Head of Department and associate professor in the Department of Mercantile Law and holds the degrees BLC, BCom(Hons), LLB, LLM (Pret), MCom (UJ) LLD (NWU), an AIPSA Diploma (AIPSA/Pret), a Diploma in Alternative Dispute Resolution (AFSA/ Pret) and a Diploma in Corporate Law (UJ). His LLD thesis is titled Employee participation and voice in companies: A legal perspective. In March 2017, he delivered his inaugural address titled ‘First do no harm! On oaths, social contracts and other promises: Navigating the labyrinth’.
He was a lecturer and senior lecturer in the UP Department of Mercantile Law from 1999 to 2006 and in 2009. He returned to the University of Pretoria on 1 January 2016 as Head of Department. His main areas of interest are labour law, corporate law, corporate governance and corporate social responsibility.
Professor Botha received a C2 rating from the NRF.
Dr Brits is a senior lecturer in the Department of Mercantile Law in the Faculty of Law.
His primary field of research is the law of secured credit transactions, with particular emphasis on real security rights such as mortgage and pledge. Related secondary research interests include aspects of consumer credit, banking, finance, insolvency, property and housing law. In 2012, he was awarded a doctorate in Law (LLD) by Stellenbosch University for his thesis titled Mortgage Foreclosure under the Constitution: Property, Housing and the National Credit Act. He is the author of an accredited monograph titled Real Security Law, published by Juta in 2016, and his research output to date includes 18 accredited contributions published in law journals. His work is regularly cited by other scholars in the field and his opinions have provided the basis for a number of prominent decisions made in South African courts. His research played a particularly important role in the resolution of a controversial problem in the recent Constitutional Court case of Jordaan v City of Tshwane (2017).
Dr Brits received a C2 rating from the NRF.
Professor Buys is professor in and Head of the Department of Consumer and Food Sciences.
Her research broadly focusses on the microbiological quality and safety of dairy and meat. The aim of her research is to elucidate the effect that food processing has on the physiology and structure of spoilage and pathogenic bacteria. In addition to the consequent changes expressed on a molecular level, she also assesses the effect of the greater bacterial ecology in the food matrix. The unifying theme has been to extend the shelf life of indigenous products to help meet the changing needs and demands of both developing consumers in sub-Saharan Africa and developed consumers worldwide. Her work has received international awards for its contribution to solve food safety problems in a developing world.
Professor Buys received a C1 rating from the NRF.
Professor Carstens is a professor in Applied Linguistics and Director of the Unit for Academic Literacy. She conducts research in various domains of academic literacy, including subject-specific literacy narratives, translanguaging and multimodality to scaffold students’ academic literacy.
The golden thread in her work is the compilation and evaluation of materials and interventions aimed at facilitating access to disciplinary discourses. In conjunction with two other researchers, Professors Elsabé Taljard (Department of African Languages, UP) and Mbulungeni Madiba (UCT). She received a collaborative grant from the Department of Higher Education and Training to establish an online multilingual Open Education Resource Term Bank (OERTB) for pedagogical purposes. To date glossaries in the eleven official languages of South Africa have been compiled for accounting, alternative and augmentative communication, business management, criminology, economics, speech language pathology and audiology, philosophy, political sciences, psychology and statistics.
Professor Carstens is currently also involved in two other research projects: an inter-university project funded by the South African Centre for Digital Language Resources (SADiLar) to compile an open resource multilingual corpus of academic learner texts for pedagogical use, and a project on using video data to investigate the acquisition of academic writing abilities through multimodal interactions in writing centres.
Professor Carstens received a C2 rating from the NRF.




Dr Chapwanya is a senior lecturer in the Department of Mathematics and Applied Mathematics in the Faculty of Natural and Agricultural Sciences. His research is focused in the areas of mathematical modelling, numerical analysis and scientific computing. His most recent work is concerned with the application of mathematical methods in models motivated by applications. Together with his students and collaborators, he has published several articles in ISI journals. His current research projects include the designing of qualitative non-standard finite difference schemes for differential models arising in applications, modelling vector-borne diseases that affect crops by using partial differential equations, and modelling biofilms.
In addition to conducting research projects, Dr Chapwanya is a node leader in the Centre of Excellence in Mathematical and Statistical Sciences (CoE – MaSS), where he also serves as the Focus Area Coordinator for Modelling and Analysis in Life Sciences. In 2015, he was the interim SARChI Leader for the DST/NRF Chair in Mathematical Models and Methods in Biosciences and Bioengineering. Over the past five years, he has been involved in organising three international conferences and three workshops.
Dr Chapwanya received a C2 rating from the NRF.

Dr Coetsee is a senior lecturer in the Department of Materials Science and Metallurgical Engineering in the Faculty of Engineering, Built Environment and Information Technology. She holds a PhD in Metallurgical Engineering from the University of Pretoria, and an MBA from the Heriot-Watt University, UK. She joined UP in 2016, after 25 years of working in the mining and mineral resources industry, notably at ISCOR, Kumba Resources and Exxaro Resources. At Exxaro Resources, she was the principal specialist in the area of process development for the AlloyStream process for high-carbon ferromanganese production, which was developed up to the demonstration-plant level. She has written several internationally published articles based on her research on the fundamentals of manganese ore smelting and its practical application.
Her primary area of research is extractive metallurgy (pyrometallurgy and hydrometallurgy), with a focus on process improvement and development through the application of process mineralogy, integrated with thermochemical modelling and process data analysis. Her secondary research focus area is the development of recycling processing options for hazardous end-stage materials, such as electronic waste and smelter slags.
Dr Coetsee received a C3 rating from the NRF.

Professor Coetzee is an associate professor in the Department of Mercantile Law. She studied at the University of Pretoria (UP), where she completed the degrees BCom(Law) (cum laude) and LLB (cum laude), which were followed by an LLM (cum laude) (awarded for a dissertation titled The impact of the National Credit Act on civil procedural aspects relating to debt enforcement and an LLD. The title of her LLD thesis was A comparative reappraisal of debt relief measures for natural person debtors in South Africa
Her primary field of research is natural person insolvency law, with a focus on No Income No Asset debtors. Related secondary research interests include consumer credit law, aspects of poverty law and the law of civil procedure. She is an attorney of the High Court of South Africa (Gauteng North Provincial Division) and is, among others, a member of the World Bank Working Group for the Treatment of the Insolvency of Natural Persons. Professor Coetzee has written numerous academic articles published both nationally and internationally in accredited journals and was a core reviewer of the Report on the Treatment of Insolvency of Natural Persons (2012), which had been commissioned by the World Bank through the Legal Vice-Presidency – Working Group of the Insolvency Law Task Force.
Professor Coetzee received a C1 rating from the NRF.
Professor Coetzee is the Director of the Centre for Geoinformation Science and associate professor in the Department of Geography, Geoinformatics and Meteorology in the Faculty of Natural and Agricultural Sciences.
Her research focusses on the ever-increasing volumes of geographic information and the challenges of making these available, accessible and usable. The research is interdisciplinary, mainly in the field of geoinformatics and computer science. The concept of a spatial data infrastructure (SDI) underlies most of her research. Her specific research foci are address data, standards, open principles, geoinformatics education and geovisualisation. As an active participant in ISO/TC 211, Geographic Information/Geomatics, Professor Coetzee initiated the development of addressing standards and led the project for ISO 19160-1:2015, Addressing – Part 1: Conceptual model. At the national level, she led the standard on addressing developed by SABS/TC 211. Her involvement in standards has led to publications by the United Nations Committee of Experts on Global Geospatial Information Management (UN-GGIM). In 2015, she was a winner in the Universal Postal Union (UPU) Addressing Solution Design Challenge for proposing a mobile app that displays addresses in augmented reality.
Over the past eight years, her collaboration with more than 50 peers from at least 20 countries resulted in 65 peer-reviewed publications and seven technical reports. She has also presented keynote addresses at several international events. As Chair of the International Cartographic Association’s Commission on SDI and Standards, she coordinates collaborative research conducted by Commission members from more than 20 countries. Through GeoForAll she participates in a global network of universities involved in geospatial education.
Professor Coetzee received a C1 rating from the NRF.
Professor Coetzee is an associate professor in the Department of Accounting in the Faculty of Economic and Management Sciences. He teaches an intermediate-level accounting course and has taken a leading role in the accounting education component of the Department’s staff development programme, as well as the master’s and PhD programmes.
His studies for both his master’s and PhD degrees focused on Accounting Education. His PhD was completed under the supervision of Professor Elizabeth Gammie of the Aberdeen Business School, Robert Gordon University. Professor Coetzee was a co-author of the first paper published by South African-based authors in Issues in Accounting Education (A-rated on the Australian Business Deans Council (ABDC) Journal Ranking List) and the B-rated Journal of Accounting Education. To date he has co-authored three papers published in Issues in Accounting Education. He was ranked joint 10th out of 598 scholars and is the highest-ranking South African scholar on the Brigham Young University Accounting Education Research rankings (based on the past six years). This has contributed to the University of Pretoria being ranked third out of 252 institutions and the Department of Accounting being ranked in the 151–200 group of Accounting Departments on the QS World University Rankings by Subject 2016 – Accounting and Finance.
He is a member of the editorial review boards of Issues of Accounting Education and Accounting Education (B rated). Currently he is a guest associate editor for a special edition of Accounting Education, which will consider papers that are of relevance to accounting education in Africa.
Professor Coetzee received a C1 rating from the NRF.
Professor Craig is a professor of mechanical engineering in the Faculty of Engineering, Built Environment and Information Technology. He has been with the department since 1993, apart from five years in industry from 2007 to 2012.
His area of research is the application of Computational Fluid Dynamics (CFD) and other numerical simulation techniques with mathematical optimisation to different mechanical engineering applications to optimise and improve engineering designs. This initially included industrial applications like continuous casting, automotive crashworthiness and electronics cooling, but more recently he has started to focus on solar and other renewable energy applications. Two specific fields of the latter are currently being investigated. The first is the optimal design of concentrated solar receivers, while the second considers wind load prediction on solar reflectors that concentrate sunlight. For this second field, atmospheric wind modelling is required and this has led to new applications in the field of wind energy and the ecological impact of wind.



He regularly contributes to international conferences on concentrated solar power and his publications in this field, together with the supervision of several postgraduate students, are receiving increasing attention.
Professor Craig received a C2 rating from the NRF.

Professor Cromarty is a professor in the Department of Pharmacology in the Faculty of Health Sciences.
His research is mainly focused on developing analytical liquid chromatography tandem mass spectrometry methods for clinically relevant small molecule analysis, metabolomics and proteomics to support pharmacological research and drug development studies. His research encompasses pre-clinical assays during drug development and discovery, pharmacokinetics, drug- and safety-related evaluations during clinical trials and pharmacovigilance phases, and assessing pharmacogenomic effects.
His proteomic research was initially directed towards malaria research and now includes hepatotoxicity assessment and wound healing research that includes developing a skin replacement product. Metabolomic evaluations are related to cancer research to identify differences between benign and metastatic cancer environments. Professor Cromarty is involved in many research projects in various local health science, veterinary, forensic and biochemistry departments that require new methods to assess safety and outcomes in early drug development, as well as advanced validated analysis where biomarkers are being pursued. He presently collaborates with international researchers from Cambridge and Ghent. He is the former chairperson of the South African Association of Mass Spectrometry.
He has supervised more than 100 BSc honours, 25 MSc and nine PhD students since 2004.
Professor Cromarty has a C2 rating from the NRF.

Dr De Vries is a senior lecturer in the Department of Industrial and Systems Engineering in the Faculty of Engineering, Built Environment and Information Technology (EBIT).
Enterprise Engineering (EE) is an emerging discipline that aims to address several phenomena concerning the evolution of enterprises. EE addresses a particular phenomenon, ie the inability of enterprises, as complex socio-technical systems, to adapt swiftly to rapidly changing environments. Although numerous theoretical design approaches (with methodologies, frameworks and modelling languages) exist, there is little empirical evidence of their effectiveness in reducing strategic initiative failures by creating unity and integration across multiple enterprise design domains. A multidisciplinary initiative, jointly presented by the Department of Industrial Engineering and the Department of Informatics provides postgraduate students with an opportunity to contribute towards the EE knowledge base.
In 2016 Dr De Vries, with the support of the Department of Industrial Engineering, organised a seminar during which theory on the Design and Engineering Methodology for Organisations (DEMO) was presented. She represents the University of Pretoria as a member of the CIAO! Enterprise Engineering Network (CEEN), which is a community of academics and practitioners from 13 universities who contribute to the development of EE and its practical application.
Dr De Vries received a C3 rating from the NRF.

Professor Du Plessis is an associate professor and Head of the Department of Architecture in the Faculty of Engineering, Built Environment and Information Technology. Her research is aimed at developing the principles and guiding frameworks for the practices of sustainable construction and human settlement development, with a focus on resilience and regeneration. In 2016, she received the AfriSam-SAIA Award for Sustainable Architecture for her book titled Designing for hope: pathways to regenerative sustainability. She is a board member and leader of the Priority Theme Sustainable Construction of the International Council for Research and Innovation in Building and Construction (CIB) and a member of the International Standards Organisation working group focusing on the resilience of buildings and civil engineering works.
She currently leads a long-term project, funded by an NRF Global Change, Sustainability and Society grant, to determine how concepts such as resilience and regenerative design would influence the way we think about urban sustainability in the context of global grand challenges. The project explores both the development of the theoretical bases for these concepts and their application in practice. Collaborating institutions include the Delft University of Technology and the University of Melbourne.
Professor Du Plessis received a C1 rating from the NRF.
Professor Ehlers is professor, Head of Research and Senior Medical Scientist in the Department of Medical Microbiology in the Faculty of Health Sciences at the University of Pretoria and the National Health/NHLS.
Her research activities focus on clinically relevant bacterial pathogens associated with infectious diseases, with special emphasis on the emergence of antibiotic resistance and the associated mechanisms, as well as the genetic relatedness of these bacterial pathogens circulating in clinical settings. Various molecular techniques, including whole genome sequencing, are used to investigate these bacterial pathogens. The research is further extended to form part of the One Health Approach which investigates the circulation of these antibiotic resistant bacteria in animal populations and the environment and to determine the potential public health risks. Bacterial pathogens under investigation include methicillin resistant Staphylococcus aureus (MRSA), other Staphylococcus species, Enterococcus species, Clostridium difficile, members of the Enterobacteriaceae and Pseudomonas aeruginosa. Microbiome studies on chronic lung diseases, such as cystic fibrosis (CF), chronic obstructive pulmonary disease (COPD) and bronchiectasis in the context of HIV infection (HIV infection increases the risk of lung diseases such as bronchiectasis and COPD) are also researched to provide new knowledge to improve patient treatment and future care.
Professor Ehlers has been an NRF-rated researcher since 2007 and received a C3 rating.

Professor Erasmus is an associate professor in the Department of Animal and Wildlife Sciences in the Faculty of Natural and Agricultural Sciences. Prior to joining UP in 2002 he was a specialist researcher at the Agricultural Research Council, focussing his research on the protein and amino acid nutrition of dairy cattle.
His current research emphasis is on the use of natural feed additives such as phytonutrients and yeast to replace antibiotics in dairy and feedlot cattle diets. He is also involved in research on the impact of feed additives on the duodenal amino acid profile of ruminants in order to improve the accuracy of nutritional models.
Professor Erasmus’ research has been published in 54 peer reviewed journals. He is a prior recipient of the silver medal of the South African Society of Animal Science (SASAS) and the Barney van Niekerk Award for Significant Research Contribution to the South African feed industry. He has supervised 31 master’s and five PhD students, and established student exchange programmes between UP and the universities of Sassari (Italy) and California, Davis, in the USA.
Professor Erasmus is registered with the South African Council for Natural Scientific Professions (SACNASP), a member of SASAS, the American Dairy Science Association and the American Registry of Professional Animal Scientists.
Professor Erasmus received a C1 rating from the NRF.
Professor Friedland has been a permanent staff member of the Department of Physics since 1957. He was Head of Department from 1980 until his retirement in 1998. He was reappointed as an emeritus and extraordinary professor until 2017.
After receiving a DSc in Physics from UP in 1965, he spent a postdoctoral year at the Kernforschungszentrum Karlsruhe (KfK). While on sabbatical leave he worked as a guest scientist at the MPI für Kernphysik in Heidelberg (1974 and 1991), the KfK in Karlsruhe (1979) and the MPI für Metallphysik in Stuttgart (1989). Joint research projects with the MPI Heidelberg, the KfK and the University of Jena led to numerous visits to these institutions between 1994 and 2011.
He has served on various committees and boards, including the South African Institute of Physics from 1989 to 1992, and the FRD Evaluation Committee (Physics), from 1996 to 1999. In 1999 he was the convener of this committee. He was a member of the FRD Institutional Research Development Programme Advisory Committee of the University of the North from 1997 to 2001 and the NRF Institutional Capacity Development Grants Advisory Committee of the University of Zululand from 2002 to 2005.
Professor Friedland received a C2 rating from the NRF.



Professor Gaigher is an associate professor in the Department of Science, Mathematics and Technology Education in the Faculty of Education.
Her research interests include physics education, inquiry-based science education and science teacher development, and are focused on the development of science teachers, future scientists and a scientifically literate population.
Professor Gaigher regularly participates in international conferences and symposia and has been invited to participate in international research and developmental projects on inquiry-based science education. She recently participated in a developmental project initiated by the French Academy of Science to support the use of inquiry-based science education according to the La main à la pâte approach in South African primary schools. She is currently involved in a large-scale international study lead by the Illinois Institute of Technology on learner understanding of scientific inquiry.
Within the last three years she has successfully supervised three master’s students and received the Best Paper Award in recognition of her outstanding contribution to interdisciplinary research from the Society of Interdisciplinary Business Research at its annual conference in Sydney, Australia, in April 2017.
Professor Gaigher received a C2 rating from the NRF.

Professor Getachew is an associate professor at the Department of Economics, Faculty of Economic and Management Sciences. He was among the winners of the 2015 and 2016 Best Researchers in Economic Sciences Awards in the Faculty. Before joining the University of Pretoria, Professor Getachew has been a Research Fellow at Durham University Business School, UK, a research consultant and a PhD Fellow at UNU-MERIT, Maastricht University, The Netherlands.
His research interest lies in the fields of macroeconomic development, with a special focus on economic growth, public investment and policy, inequality and social mobility, from both theoretical and empirical perspectives. His work aims to understand the effects of public policy on the dynamics of inequality and intergenerational mobility, and the subsequent impact on economic growth and welfare. Each of these is an area of great importance to the developing world, especially, sub-Saharan Africa where he is from and is based. Professor Getachew has published peer-reviewed papers in highly reputed A-rated international journals including the Journal of Macroeconomics, Macroeconomic Dynamics, Economics Modelling, and Economics Letters
Professor Getachew received a C2 rating from the NRF.

Professor Goddard is a professor of clinical pathology in the Department of Companion Animal Clinical Studies in the Faculty of Veterinary Science.
She currently serves as Acting Head of the Department. Her research focus is predominantly on understanding the interaction between systemic inflammation and haemostasis (coagulation), using unique animal models such as canine babesiosis, canine parvovirus enteritis, canine spirocercosis and snake envenomation. Haemostatic abnormalities in inflammatory disease conditions, specifically the risk of organ failure secondary to microthrombosis, are unexplored, yet very relevant, in animal diseases. Her research has provided insight into the complex host response to systemic inflammation and its effect on haemostasis. Moreover, it highlighted the central role of the platelet in inflammation and its interaction with other inflammatory cells. Professor Goddard received the award for Best Oral Research Presentation at the 2013 congress of the European Society of Veterinary Clinical Pathology that was held in Berlin, Germany. She has since been invited as keynote speaker to the congress of the International Society for Clinical Pathology in 2014 (Denmark), and again in 2018 (Japan). In 2016 she was listed as one of the top ten researchers in the Faculty of Veterinary Science.
Professor Goddard received a C2 rating from the NRF.
Professor Green is the Director of Paediatric Services and Paediatric Pulmonology, Paediatric Intensive Care and Allergy Services at the Steve Biko Academic Hospital, Pretoria, and professor in the Department of Paediatrics and Child Health in the School of Medicine at the University of Pretoria.
He holds PhD and DSc degrees and is a Fellow of the Royal College of Physicians, the American Academy of Allergy, Asthma and Immunology, and the American College of Chest Physicians. He is a former president of the College of Paediatricians of South Africa and was, until very recently, the chairperson of the Allergy Society of South Africa.
He has published 140 peer-reviewed scientific publications and has presented more than 300 national and international papers.
Professor Green received a C2 rating from the NRF.
Professor Grobler was Head of the Department of Business Management for four years.
She has now returned to her home division of Communication Management where she focusses on master’s and doctoral study guidance in the following research areas: stakeholder relationship management, communicating corporate governance and sustainability, corporate social responsibility, general strategic communication management and marketing communication.
Professor Grobler has received three NRF ratings since joining the University of Pretoria in 2001, and currently holds a C3 rating.


Professor Gruner is an associate professor in the Department of Computer Science, Faculty of Engineering, Built Environment and Information Technology. He works in the area of formal software specification and verification techniques, specifically modelchecking. Moreover, he is also interested in science-philosophical questions concerning the ontological, epistemological, methodological and historical foundations of computer science and its relations with other academic disciplines.
Together with Postdoctoral Research Fellow Nils Timm, Professor Gruner received the Best Paper Award at the SBMF2014 conference, the Second Best Paper Award at the SBMF2016 conference, as well as recognition as one of the top three contributors at the FSEN2017 conference.
Professor Gruner received a C2 rating from the NRF.


Professor Tharina Guse is professor and Head of the Department of Psychology in the Faculty of Humanities.
Her broad research interest is in the field of positive psychology. In particular she is interested in examining factors related to the well-being of the youth, which include interventions designed to maintain and promote their psychological well-being. She further investigates the nature, dynamics and mechanisms of psychological strengths, specifically hope and gratitude. These positive characteristics are strongly associated with psychological well-being across an individual’s lifespan. Finally, Professor Guse examines the use of hypnosis to promote mental health.
Professor Guse has, on several occasions, been invited as a visiting professor to the University of Bologna, Italy, to present postgraduate lectures and provide postgraduate research supervision on hypnosis and psychological well-being. In 2016, she was awarded an Erasmus scholarship to study at the University of Porto in Portugal. She was recently elected as a founding president of the South African Positive Psychology Association and is a member of the Professional Board of Psychology of the Health Professions Council of South Africa.
Professor Guse received a C2 rating from the NRF.

Dr Almuth Hammerbacher is a senior lecturer in the Department of Zoology and Entomology in the Faculty of Natural and Agricultural Sciences.
She is employed as a research scientist at the Forestry and Agricultural Biotechnology Institute (FABI) and heads the Max Planck Chemical Ecology Partner Group which was established between UP and the Max Planck Society in 2016. Her research focuses on the chemical communication between plants, animals and microbes.
She is specifically interested in positive chemical signalling in mutually beneficial microbe-insect and microbe-plant associations, as well as negative chemical signals between host plants and their microbial or arthropod attackers. She also studies the biochemical and ecological forces driving organismal adaptation. In this context she focusses on studying biochemical drivers resulting in host specificity in tree pests and pathogens. Her research combines methodologies from diverse fields of specialization, including ecology, natural product biosynthesis and analysis, enzymology, genetics, plant physiology, genetic engineering and microbiology.
Dr Hammerbacher received a C1 rating from the NRF.

Professor Hanekom is professor in the Department of Electrical, Electronic and Computer Engineering, Faculty of Engineering, Built Environment and Information Technology. She is the Function Head for undergraduate studies in the Department. Her research is in computational physiology of the electrically stimulated human auditory system. The research aims to create user-specific computer models of the auditory periphery of cochlear implant (CI) users with the objective to develop clinical tools to allow non-invasive model-based diagnostics and model-predicted customisation of device parameters. The research involves a range of topics such as anatomical landmarking to provide a geometric reference for the models, and neural modelling. The models have been applied to investigate facial nerve stimulation as a complication of CI use and to predict the prognosis over the long term for a specific user suffering from this complication. The models also allow possible solutions to complications to be investigated. To facilitate translation of the models to the clinical domain, the research also aims to find rapid model generation techniques that will allow greater access to the technology for the CI community.
Professor Hanekom is the author or co-author of more than 50 journal and conference outputs and received numerous teaching and learning awards, among others the Chancellor’s Award for Teaching and Learning in 2017.
Professor Hanekom received a C2 rating from the NRF.
Dr Hoareau is a Senior Postdoctoral Fellow in the Department of Biochemistry, Genetics and Microbiology in the Faculty of Natural and Agricultural Sciences. He is one of the core team members of the Molecular Ecology and Evolution Programme, and leads a group that tackles ecological and evolutionary questions related to the marine environment. He holds a PhD in the field of marine biology and genetics, and has taken part in multiple projects in Réunion, France, South Africa and West Africa. His main research objective is to study marine species of conservation importance to better understand the processes and factors influencing their demography.
His sustained research activity is facilitated by research grants, continuous mentoring activities and a large collaborative network. He has published 26 papers in marine biology and genetics, some in high-profile peer-reviewed journals. He has been invited to present his work at conferences and serves as a referee in the peer review process of multiple international journals. He is involved in initiatives to advance marine sciences across the continent. He is a founding member of ConnectUs, a web-based platform within the Future Africa initiative developed to connect African scientists and to improve their visibility.
Dr Hoareau has a C3 rating from the NRF.
Professor Hofmeyr is a professor of philosophy in the Faculty of Humanities, affiliated to the University of Pretoria on a full-time, permanent basis since 2009.
She lived and worked in the Netherlands while completing her doctoral studies and postdoctoral research. She maintains strong collaborative ties with Radboud University Nijmegen, where she obtained her doctoral degree in Philosophy on the work of Foucault and Levinas. Her research interests fall within the broad ambit of contemporary continental philosophy (especially thinkers following in the wake of Heidegger, with emphasis on post-structuralism and phenomenology) with an enduring fascination for the inextricable entanglement of the ethical and the political. She reflects through both her teaching and research on the entanglement of European and non-Western, especially post-colonial African, philosophy and the possibility of a dialogue across these divergent yet fundamentally intertwined traditions of thought.
Professor Hofmeyr has a C2 rating from the NRF.
Dr Hannelie Human is a Research Fellow in the Department of Zoology and Entomology in the Faculty of Natural and Agricultural Sciences. With her research, she aims to increase our understanding of factors that may contribute to the loss of honeybee colonies in South Africa. More specifically, she investigates the effect of nutrition, pesticides, pathogens and parasites which, when interlinked, adversely affect both honeybee health and plant-pollinator interactions.
Her work contributes to our knowledge in the field of pollinator identification and pollination efficiency, the quality of floral rewards (nectar and pollen) and, more recently, the effect of neonicotinoid pesticides on honeybee physiology, behaviour and nutrition. She has co-supervised one PhD, two master’s and six honours students. Her publications include 26 peer-reviewed articles, 18 popular articles and book chapters. At the local level she is involved with various key role players and stakeholders in the beekeeping industry in South Africa, including the Department of Agriculture, Forestry and Fisheries, the Agricultural Research Council, the South African Bee Industry Organisation and beekeepers.
She is a member of two international honeybee research networks that focus on the monitoring and prevention of colony losses and the global conservation and management of pollinator ecosystem services.



Dr Human received a C2 rating from the NRF.

Professor Joubert is a member of the World Education Research Association and serves on the management committee of the South African Research Association of Early Childhood Education. She recently participated in the national evaluation panel for scholarly outputs constituted by the Department of Higher Education and Training. The Academy of Science of South Africa also invited her to share her expertise as part of the peer review panel for the evaluation of South African scholarly journals.
Professor Joubert specialises in democratic citizenship education and language education of the young child. She has published articles on her research in these fields in accredited national and international journals. She is the editor and author of scholarly books on these foci and also contributed subject-related books and book chapters. She serves on the editorial board of the South African Journal of Education
As head of the Department of Early Childhood Education, she assisted in securing a R3 million grant from the European Union and DHET for a project to develop a new BEd qualification which focusses on the preparation of student teachers for 0 to 4-year old children.
Professor Joubert has mentored several postgraduate students in Foundation Phase Education to completion of their studies. Some of the students who completed their degrees under her supervision have excelled in their careers.
Professor Joubert received a C3 rating from the NRF.

Professor Kearsley is professor in the Department of Civil Engineering in the School of Engineering of the EBIT faculty. Her research focus is reducing the environmental impact of the cement and concrete industry through research on the use of waste materials in cement and concrete, optimized concrete mix compositions to minimise wastage, actual material properties for refining concrete design assumptions, ultra-high strength and fibre-reinforced concrete for the improvement of concrete properties so that concrete elements with smaller cross sections can be used in reinforced concrete structures, and the effect of soil-structure interaction on the actual stresses that develop in reinforced concrete structures in order to improve the design assumptions for reinforced concrete pavements and footings.
Professor Kearsley was the first author of the paper that received both the JE Jennings Award for the best paper published by a South African author in 2014 and the 2017 Individual Award for Transportation from the South African Institute of Civil Engineering (SAICE). She was one of the co-authors of the paper ‘Fracture banding in caving mines’ that received a gold medal from the Southern African Institute of Mining and Metallurgy (SAIMM) in 2016.
Professor Kearsley received a C1 rating from the NRF.

Professor Killander is Professor of Human Rights Law in the Centre for Human Rights, Faculty of Law. His main research area is international human rights law and comparative constitutional law, with a focus on the interaction between international and national law. Bringing together students from across Africa and beyond, Professor Killander is the academic coordinator of the Centre’s flagship programme, the LLM/MPhil (Human Rights and Democratisation in Africa) which is presented in collaboration with partner universities across the African continent.
Professor Killander is editor-in-chief of African Human Rights Law Reports, on the editorial board of the Oxford Reports of International Law and co-editor of the African Human Rights Law Journal. He has published extensively in local and international journals and contributed to books published by leading publishers. He has consulted with international organisations such as the United Nations and the African Union and was the lead contributor of the Centre in an international collaborative project on fostering human rights in policies of the European Union.
Professor Killander received a C2 rating from the NRF.
Professor Kleyn is an associate professor and Dean of the Gordon Institute of Business Science. Her research is conducted in the discipline of marketing with a focus on management of corporate branding and corporate reputation. In 2016 she was awarded a Citation of Excellence by Emerald Group Publishing as the author of one of the most highly cited and influential papers published in 2012 relating to the areas of business management, finance, accounting, economics and marketing.
Professor Kleyn received a C1 rating from the NRF.
Professor Kriel is a professor in Visual Culture Studies in the Department of Visual Arts in the Faculty of Humanities. Her research interest is in missionary archives, book history, and the material culture of image and text production. She is a Fellow of the Alexander von Humboldt Foundation. In 2016 she obtained a grant from the National Institute for the Humanities and the Social Sciences. This enabled her to continue collaboration with colleagues in Germany and South Africa on the Hoffmann Collection of Cultural Knowledge, which by 2015 had culminated in an online database of archival material, and an annotated sourcebook. The current project, on which exhibitions were held in 2016 and 2017, is aimed at the further contextualization and continued application of the Hoffmann material, and is titled The Berlin Mission Archive as a Repository of African Knowledge.
Professor Kriel received a C2 rating from the NRF.
Professor Landman, an associate professor in the Department of Town and Regional Planning in the Faculty of Engineering, Built Environment and Information Technology, is a qualified urban designer and planner with a background in architecture. She focusses on the transformation and redevelopment of the public realm within cities. Her current research interests relate to public spaces, spatial transformation, nodal development, sustainable neighbourhoods, urban resilience and regenerative development and design. Her other areas of research and professional experience include crime prevention in the built environment, gated communities, urban segregation and medium-density mixed housing.
She leads a multi-year NRF project on the transformation of public spaces in South Africa and is currently working on a book titled The Evolution of Public Space in South Africa.
Professor Landman received a C2 rating from the NRF.




Professor McGaw is an associate professor in the Department of Paraclinical Sciences.
Since 2015 she has headed the Phytomedicine Programme, which has an extremely productive research group that generates a large number of publications and delivers several PhD and MSc graduates every year. Based in the Faculty of Veterinary Science, research conducted by the group focusses on the use of plants to improve animal health.
Professor McGaw’s current interests include evaluation of the antimicrobial, anthelmintic, antimycobacterial, anti-inflammatory, cytotoxic, mutagenic and antimutagenic effects of plant extracts and purified compounds derived from plants. She is also interested in the immune modulatory activity of plant preparations. Cell culture applications and mechanism of action studies are particular focus areas incorporated into her various projects. The research emphasis of the Phytomedicine Programme targets the development of effective and safe anthelmintic acaricidal and antimicrobial remedies for use in animal and human medicine, as well as alternatives to antimicrobial feed additives.
Professor McGaw is the theme leader of one of four newly launched research themes in the Faculty of Veterinary Science, namely Translational Medicine. She serves on several editorial boards and has published close to 100 articles in ISI-rated journals.
Professor McGaw has a C2 rating from the NRF.

Professor McNeill is an associate professor and subject co-ordinator of Anthropology in the Department of Archaeology and Anthropology. His research focusses on diverse aspects of the Vhavenda in South Africa. Professor McNeill has published widely on traditional leadership, HIV/AIDS education, popular culture, ethnicity, ritual, poisonings and gossip. He is the author of AIDS, Politics and Music in South Africa (hardback 2011, paperback 2014) which was based on his PhD thesis from the London School of Economics (2007). The thesis was awarded the Audrey Richards Prize by the Association of Social Anthropologists.
He recently received an Indigenous Knowledge Systems research grant from the NRF to facilitate and document the ritual translation of human rights discourse into the ritual curriculum of Venda male initiation.
Professor McNeill received the award for best lecturer in the Faculty of Humanities for 2017. He is a member of the editorial board of Anthropology Southern Africa, and has recently completed a research paper on an interlocutor who turned into a hyena. Outside of academia, he runs a recording studio in Thohoyandou and is the rhythm guitarist in a Venda reggae band.
Professor McNeill received a C2 rating from the NRF.

Professor Meyer is an associate professor in the Department of Old Testament Studies in the Faculty of Theology and Religion.
Professor Meyer specialises in the Pentateuch and focusses specifically on P (priestly) and post-P texts in the Pentateuch, which includes the book of Leviticus. He has published extensively on different chapters from the book of Leviticus, engaging with themes such as eco-theology, strangers, land and ritual innovation. He is interested in the relation between ritual and identity, as well as ritual and ethics. He is also fascinated by how these texts functioned in the Persian or Second Temple period as either resisting or appeasing the Persian empire.
He was elected as treasurer of the Old Testament Society of South Africa in 2016 and voted Lecturer of the Year in the Faculty of Theology in 2015.
Professor Meyer has a C2 rating from the NRF.
Dr Ntumba is a senior lecturer in the Department of Mathematics and Applied Mathematics in the Faculty of Natural and Agricultural Sciences. He holds a PhD degree from the University of Cape Town.
Dr Ntumba was selected, based solely on merit, for a two-month research visit at the Institut des Hautes Études Scientifiques, Paris, France, December 2012 to January 2013. He is a member of the International Mathematical Association, the Group Action Forum and the Southern Africa Mathematical Sciences Association. He acts as referee for two international journals, namely Asian-European Journal of Mathematics and Demonstratio Mathematicae.
One of his more recent important publications is an article titled ‘The symplectic GramSchmidt theorem and fundamental geometries for A-modules’ that was published in the Czechoslovak Mathematical Journal, vol. 62 (2012), issue 1. Dr Ntumba’s area of research includes commutative algebra and abstract differential geometry.
Dr Ntumba received a C3 rating from the NRF.
Dr Oosthuizen is a Research Career Advancement Fellow in the Department of Zoology and Entomology in the Faculty of Natural and Agricultural Sciences.
She is a behavioural physiologist whose research focusses primarily on the sociality of small mammals. Her research includes comparative studies between solitary and social species and intra-species differences within the social hierarchy of social species. These differences are investigated at a behavioural, physiological and neurological level. Furthermore, she is interested in how fluctuating environmental factors such as light and ambient temperatures affect the behaviour and physiology of animals. This research provides insight into how animals react and adapt to a changing environment and may have conservation implications. She supervises several postgraduate students in related projects. Dr Oosthuizen was awarded an Exceptional Young Researcher Award from the University of Pretoria in 2013. She regularly publishes articles in peer-reviewed journals and acts as reviewer for several journals.
Dr Oosthuizen received a C2 rating from the NRF.
Dr Ouifki is a senior lecturer in the Department of Mathematics and Applied Mathematics in the Faculty of Natural and Agricultural Sciences.
His research is mainly focussed on the mathematical modelling and analysis of the transmission dynamics of communicable and non-communicable diseases such as HIV, tuberculosis, malaria, trypanosomiasis and cancer. The inherent complexity of these problems requires a wide variety of approaches ranging from mathematical to numerical analysis. Approaches include stability and bifurcation theory, asymptotic behaviour and perturbation theory of ordinary, delayed and partial differential equations to optimal control theory, along with parameter optimisation and sensitivity analysis.
His other research interests include stability and bifurcation, ordinary and delayed differential equations and optimal control cost benefit and cost-effectiveness analyses.
Dr Ouifki received a C2 rating from the NRF.




Dr Panebianco is a senior lecturer in the Department of Music. She lectures on undergraduate music history, music psychology and research methodology, and supervises numerous postgraduate students in both historical and systematic musicology. She is Chair of the Department’s Music Proposals Committee.
Following her interest in psychology, her research focus changed from historical to systematic musicology when she completed an MA in Psychology for Musicians at the University of Sheffield in 2013 (cum laude).
She served on the Ethics Committee of the Faculty of Humanities for several years. Dr Panebianco conducts peer reviews for local and international journals, and regularly acts as external examiner for postgraduate studies at various universities across South Africa. Her research is broadly focused on health and wellbeing issues in performing artists. She has presented at several national and international conferences. Aside from her academic activities, she is an oboist and regularly plays with various professional orchestras, ensembles and community orchestras. Her future plans include expanding research into musculoskeletal and other health-related issues in performing artists, as well as exploring the impact of informal music-making on societal wellbeing in the South African context.
Dr Panebianco has a C3 rating from the NRF.

Professor Pikirayi is a professor of archaeology and Head of the Department of Anthropology and Archaeology.
His research interests are in the origins, development and decline of ancient civilizations in southern Africa, focussing on the archaeology of the Zimbabwe culture and using a combination of conventional approaches, archaeometry, and geo-archaeology. In 2014 and 2016 he was awarded the University of Pretoria Faculty of Humanities Researcher of the Year Award in the Social Sciences Cluster. In 2017 he was appointed ambassador of the journal Antiquity: a review of world archaeology, to encourage and support article submissions from archaeologists based in, and working on, regions of the world such as Africa that are less well represented in the journal.
Professor Pikirayi has a C1 rating from the NRF.

Professor Pretorius has more than 40 years’ experience in the professional, engineering, academic and academic management domains. He holds the degrees BSc (Hons) Engineering, BSc (Hons) Mathematics, MScEng, MSc (Math) and DEng from the University of Pretoria. In 2005 he was Executive Dean of Engineering and the Built Environment at the University of Johannesburg and he is currently professor in the Graduate School of Technology Management at UP. He has been active as specialist consultant and researcher in the engineering industry since 1980.
Professor Pretorius has supervised more than 240 master’s and PhD students in engineering, as well as students of engineering and technology management on their master’s research projects, dissertations and doctoral theses. This includes the supervision of 51 successful PhD students. He has published more than 260 technical conference papers and peer reviewed journal articles as author and co-author in his fields of expertise. He serves on the editorial boards of a number of international journals. He is currently the chairperson of the International Association for Management of Technology (IAMOT) board, an honorary Fellow of the South African Institution of Mechanical Engineering (SAIMechE), and member of the Southern African Institute for Industrial Engineering (SAIIE), the American Society of Mechanical Engineers (ASME) and the Institute of Electrical and Electronics Engineers (IEEE) in South Africa. He has been the recipient of an Eskom TESP grant for more than 22 years.
Professor Pretorius received a C1 rating from the NRF.
Professor Pretorius is a professor specialising in strategy, turnaround and leadership in the Department of Business Management, Faculty of Economic and Management Sciences.
As a strategy consultant and facilitator he focusses on distressed ventures in search of rescue and growth. Research interests from his publication record suggest turnaround post mortem analysis, modelling, business rescue practitioner tasks and competencies, strategy critiques, leadership and simulation as areas of interest. As motivational and public speaker he is a devil’s advocate who enjoys challenging the so-called normal.
Professor Pretorius received a C2 rating from the NRF.
Professor Quan is an associate professor and veterinary virologist in the Department of Veterinary Tropical Diseases in the Faculty of Veterinary Science at Onderstepoort.
He studied Veterinary Science at the University of Pretoria, after which he continued his studies at the University of Edinburgh, where he was awarded a PhD for his research on the quantitative dynamics of the foot-and-mouth disease virus in pigs. He is involved in the development of rapid, multiplex diagnostic assays for diseases of veterinary importance, using polymerase chain reaction (PCR) and Luminex xMAP® (multi-analyte profiling) technologies, and is currently developing multiplex assays for haemoparasites of veterinary importance, for causes of abortion in cows and for Simbu orthobunyaviruses. He is also involved in research which attempts to explain the molecular and spatial epidemiology of disease outbreaks, such as peste des petits ruminants and African horse sickness.
Professor Quan received a C3 rating from the NRF.
Dr Rademeyer is a senior lecturer in the Department of Chemistry, Faculty of Natural and Agricultural Sciences.
She has a keen interest in the field of materials science, with her research group focussing on structure-property relationships in multi-functional hybrid materials with applications in renewable energy. One of the aims of her research is the design of novel, low band gap hybrid materials using non-covalent interactions as structure-directing forces. Her research focus areas are the application of novel hybrid materials as solar cell sensitisers to improve solar cell efficiency, as well as the control of the magnetic and optical properties of the hybrid materials via structural design.
Dr Rademeyer received a C3 rating from the NRF.




Professor Renke is an associate professor in the Department of Mercantile Law in the Faculty of Law.
His primary field of research is the law of credit, specifically the National Credit Act 34 of 2005, and he has authored and co-authored numerous articles on this topic. He studied at the University of Pretoria, where he completed the degrees BLC, LLB, LLM and LLD. His doctoral thesis was titled ‘An evaluation of debt prevention measures in terms of the National Credit Act 34 of 2005’. He was admitted as an attorney of the High Court of South Africa in 1992. After 12 years of service as a military legal officer in the SA National Defence Force, he joined the Department of Procedural Law as a part-time lecturer in 1999. He subsequently served as part-time lecturer in the Department of Mercantile Law in 2000 and 2001 and was appointed full time in 2002. He was promoted to senior lecturer in 2004 and to associate professor in 2016.
Professor Renke received a C2 rating from the NRF.

Professor Röllin has been a professor in Environmental Health and Senior Research Fellow at the School of Health Systems and Public Health (SHSPH), Faculty of Health Sciences, since 2014. She is an Honorary Chief Specialist Scientist at the Environment and Health Research Unit of the South African Medical Research Council (SAMRC).
Her research interests are exposures to toxic substances in the environmental and occupational health fields in which she has published extensively. She is involved in multinational and multidisciplinary projects that are of national and global importance in terms of persistent environmental contaminants and reproductive health and birth outcomes. These activities constantly contribute towards building research capacity, not only in South Africa but also in Norway, Russia, Australia, Brazil and Malawi.
She is a co-investigator in the recently established Nano Health, Safety and Environmental Risk Research Platform (Nano-HSE Platform) funded by the DST, which aims to develop expertise within South Africa for the assessment, identification and mitigation of health, safety and environmental risks associated with engineered nanotechnology.
Professor Röllin was instrumental in establishing research collaboration between the University of Pretoria and the State University of São Paulo (UNESP), Brazil.
Professor Röllin received a C2 rating from the NRF.

Professor Schulman is a professor in the Section: Reproduction, Department of Production Animal Studies in the Faculty of Veterinary Science. He is responsible for didactic and clinical teaching in equine reproduction for undergraduate and postgraduate veterinary students. He has successfully mentored clinical residents for specialist registration via the UP MMedVet (Gyn) programme, as well as foreign specialisation board examinations.
His research supervision record includes candidates in MSc, MMedVet (Gyn) and PhD programmes. His research focus and publication outputs are divided between immunocontraception of domestic and wildlife species and infectious diseases affecting equine reproductive performance. Successfully obtaining financing and grant awards from local and international sources, he currently has productive collaborative projects with both local researchers, notably the University’s Equine Research Centre, and internationally with the universities of Utrecht and Nottingham in Europe, as well as Ross University in the Caribbean. He co-founded the Veterinary Population Management Laboratory which coordinates research focussed on the development and application of novel immunocontraceptive vaccines in equids and elephant populations. In the South African horse industry he is widely consulted by veterinarians and breeders and advises state veterinarians on infectious reproductive disease management impacting on the international trade and movement of horses.
Professor Schulman received a C2 rating from the NRF.
Dr Simpson is based in the Department of Historical and Heritage Studies in the Faculty of Humanities. Until 2016 his research centred on the history of the armed struggle waged by Umkhonto we Sizwe, the military wing of the African National Congress in South Africa from the origins of the insurgency in the 1950s to its end in 1994. His research culminated in two publications, namely a book manuscript Umkhonto we Sizwe: The ANC’s Armed Struggle (2016), and a volume of which he was editor, The ANC and the Liberation Struggle in South Africa: Essential Writings (2017) to which he also contributed two chapters. Among the awards he has received over the past three years are the Oppenheimer Fund Fellowship from Oxford University, and a visiting professorship from the institute of political sciences, Sciences Po Lyon (both 2017).
In addition to being an NRF-rated researcher, he is also a grant holder of the National Institute for the Humanities and Social Sciences (NIHSS) for the work of the Rethinking Twentieth Century Southern Africa research group of which he is the principal investigator. His present research is towards a second book manuscript on the history of South Africa from the end of the Anglo-Boer War to the present day.
Dr Simpson received a C2 rating from the NRF.
Professor Steyn is an emeritus professor in the Department of Sport and Leisure Studies in the Faculty of Humanities, where he has lectured for the last 40 years. He is registered with the Health Professions Council of South Africa (HPCSA) as a counselling psychologist. His academic qualifications consist of seven degrees, of which four are in Sport Science and three in Psychology, as well as a Teachers Diploma.
The main goal for his DEd Sport Science and DPhil Psychology was to achieve full qualification as a sport psychological researcher and practitioner. Professor Steyn’s main research area is the reciprocal relationship between high performance and psychological well-being in the sport context, as well as in other performance-evaluative contexts such as sport and music. A highlight in his sport psychological career was his appointment as sport psychologist by the Sports Information and Science Agency (SISA) of South Africa to prepare national teams for international participation.
His most important publications with a research focus on high performance and psychological well-being cover topics such as psychological skills training, mindfulness training and psychological well-being.
Professor Steyn received a C3 rating from the NRF.
Professor Steyn is an associate professor in the Department of Social Work and Criminology who lectures in criminology theory and research methodology. His research career commenced at the Centre for Health Systems Research and Development (University of the Free State), where he compiled and co-authored numerous research and technical reports for government and development agencies, including the World Health Organization, the Ford Foundation and Save the Children. He was also the acting director of the Centre for two years before taking up a lecturing position at the University of Pretoria.
To date, Professor Steyn has published 35 articles and book chapters, presented 29 papers at local and international conferences, authored 38 research reports, and supervised 24 master’s and doctoral students in development studies and criminology. His research focusses on risk and resilience in vulnerable populations, specifically related to children in conflict with the law and female offenders. He is an editor of the academic journal Acta Criminologica and received the 2016 Lecturer of the Year Award in Applied Social Sciences Cluster.



Professor Steyn received a C3 rating from the NRF.

Professor Terblanche is an associate professor in the Department of Social Work and Criminology in the Faculty of Humanities. He has recently completed 30 years of service at the University of Pretoria.
His areas of research and expertise are social work supervision, social work management, occupational social work and employee assistance programmes.
In October 2012 Professor Terblanche received the Member of the Year Award from the Employee Assistance Professionals Association (EAPA) in Baltimore, Maryland, in recognition of his exceptional leadership in and contribution to the employee assistance profession.
In 2016 the Employee Assistance Professionals Association of South Africa (EAPA-SA) presented him with the Special Recognition Award in recognition of his excellent contribution, achievement and service to the association. In 2017 EAPA-SA acknowledged him again with the Special Recognition Award for his commitment and contributions to the employee assistance profession and the association in the form of a special project: a book on Creating legacy in EAP business: The South African approach towards Employee Assistance. The peer-reviewed book will be published in 2018.
Professor Terblanche received a C3 rating from the NRF.

Professor Theron has been a professor in the Department of Physics of the Faculty of Natural and Agricultural Sciences since 2010, where he uses the 2 MV Van de Graaff accelerator for studies of materials. His current research interests are in the reactions of ternary thin films, to establish whether specific materials are safe for use in nuclear applications and the growth and applications of nano-crystalline diamond films.
After an unsuccessful three-year tour of the arts (BA Theology) as an undergraduate, Professor Theron turned to the study of Physics, focusing on the use of ion beams to characterise solids, and thin film reactions in particular. He developed the global first in situ real-time Rutherford backscattering spectrometry (RBS) facility and lectured on this by invitation at the Ion Beam Analysis conference in Dresden (1999). Prior to joining the University of Pretoria, he headed the Materials Research Group at iThemba LABS, a national facility of the NRF, for six years and worked as a principal research scientist in a diamond research laboratory.
He is a member of the South African Institute of Physics, was a director of the not for-profit Cape Initiative for Materials in Manufacturing, and chaired the Programme Management Committee of iThemba LABS (Gauteng) and the Users Advisory Committee of iThemba LABS (Faure). He was instrumental in setting up collaboration with the Centre for Energy Research and Development in Nigeria, resulting in their successful acquisition and commissioning of a pelletron accelerator.
Apart from publications on real-time RBS, Professor Theron considers as his most important work a range of papers on predicting phase formation sequences in thin-film systems, of which one has been cited more than 100 times.
Professor Theron received a C2 rating from the NRF.

Professor Theron is a professor in the Department of Biochemistry, Genetics and Microbiology, Faculty of Natural and Agricultural Sciences.
His research activities focus on molecular virology and specifically on viruses of veterinary importance, including the African horse sickness virus (AHSV). African horse sickness, with the African horse sickness virus as aetiological agent, is a devastating disease among horses resulting in sudden death. Professor Theron’s immediate research focus is on the structural and non-structural proteins of AHSV, whose roles in viral processes such as cell entry, production of viable progeny virions, virulence and pathogenicity remain undefined but are required for the long-term goal of understanding the molecular genetic events underlying the infectious cycle of AHSV. To this end he and his team have developed and established different reverse genetic platform technologies to enable the introduction of defined mutations into the viral genome. The data generated should not only contribute substantially to unravelling the molecular mechanisms underlying AHSV propagation, but may also find application in the development of a new generation of AHSV vaccines.
Professor Theron received a C1 rating from the NRF.
Dr Turpin is a senior lecturer in the Department of Informatics in the Faculty of Engineering, Built Environment and Information Technology.
Within the field of information systems, her research interests include Information and Communications Technology for Socio-Economic Development (ICT4D), in particular the application of systems thinking methods in this domain. As part of her undergraduate teaching, she is also researching the effective teaching of problem-solving skills, critical thinking and creativity skills to undergraduate Informatics students. She received the Best Paper Award at the 2014 conference of the International Development Informatics Association, with a paper titled ‘Investigating ways to assess ICT4D’s impact on the larger community’.
Dr Turpin received a C3 rating from the NRF.
Professor Van den Berg is an associate professor in the Department of Mathematics and Applied Mathematics in the Faculty of Natural and Agricultural Sciences.
His varied research interests are all within a branch of algebra known as ring theory, and his primary focus is on torsion theory. This theory, which made its first appearance in the mid-1960s, is now supported by a rich and extensive literature. A recurrent theme in his work is his exploration of the extent to which the internal properties of a ring are encoded in its topologising filters. These filters are torsion-theoretic objects that appear when generalised notions of rings of fractions are considered. This has led to collaborative work with his Ethiopian former PhD student, Dr Nega Arega.
Professor Van den Berg has a record of publication in Communications in Algebra, the Journal of Pure and Applied Algebra and the Journal of Algebra, which are widely regarded by the community of algebraists as the three top algebra-specific mathematics journals.
His most recent publication, co-written with Dr Pham Gnoc Anh from the Mathematics Institute in Budapest, Hungary, appeared earlier this year in the Journal of Algebra, which is arguably the most prestigious of the aforementioned three. The paper uses the machinery of torsion theory to answer a longstanding open question in an area of ring theory that has traditionally been regarded as quite separate from torsion theory.
In addition to fruitful collaborative links with researchers in South Africa, he has published jointly with fellow ring theorists in Germany, Hungary, Mexico, Poland, Portugal and Romania.
Professor Van den Berg received a C1 rating from the NRF.
Dr Van der Laan is a senior lecturer in the Department of Plant and Soil Sciences in the Faculty of Natural and Agricultural Sciences.
His general research focus is on improving the sustainability of agricultural systems. His PhD thesis was on non-point source nitrogen and phosphorus pollution from agriculture, and he is continuing his research on this topic. His work has expanded to include understanding of the movement of pesticides to waterways, and providing a framework for the registration of agrochemicals in South Africa based on environmental risk. Other research interests include water footprint accounting, nitrogen dynamics in agro-ecosystems, irrigation water quality, and the application of life cycle assessment in agriculture.
Dr Van der Laan received a C2 rating from the NRF.




Dr Van der Walt is a senior lecturer in the Department of Mathematics and Applied Mathematics in the Faculty of Natural and Agricultural Sciences.
His research interests include convergence spaces, ordered spaces, set-valued analysis, nonlinear theories of generalized functions, and the connections between these different fields. He serves as chair of the Quality Teaching Committee in the Department of Mathematics and Applied Mathematics, and on the Teaching and Learning Committee of the Faculty. In 2017 he was nominated for the NAThouse Best First Year Lecturer Award.
Dr Van der Walt received a C2 rating from the NRF.

Professor Van Marle-Köster is an associate professor of animal breeding and genetics and Head of the Department of Animal and Wildlife Sciences. Her research concerns the application of genomics to animal sciences focussing on beef and dairy cattle, as well as indigenous goats. Genomics are applied in studies for genomic diversity of indigenous livestock, as well as the selection of traits of economic importance in livestock.
As a result of her keen interest in the subject she organised the first workshop on livestock genomics in 2012 which led to the establishment of a livestock genomics task team. She serves on the research and project committees of the Beef Genomic Project and the Dairy Genomic Project respectively. She has supervised 26 MSc studies to completion and delivered six doctoral students. She has published more than 50 papers in peer-reviewed journals, and contributed to congress proceedings and book chapters. She also regularly contributes to popular science papers for the South African beef and dairy cattle industry.
She is registered as a professional animal scientist with the South African Council for Natural Science Professions. In 2016 she received a silver medal in recognition of her exceptional contribution to the advancement of professionalism and knowledge in the animal science and livestock industry from the South African Association of Animal Science. She is currently the president of the South African Society for Animal Science and a member of the committee for Continuous Professional Development (CPD).
Professor van Marle-Köster holds a C2 rating from the NRF.

Professor Van Rooy has been teaching engineering geology in the Department of Geology, Faculty of Natural and Agricultural Sciences, for nearly 30 years. He has researched the suitability of the basalts in Lesotho for use in the Lesotho Highland Water Scheme and has been involved in the dolomite and sinkhole problems south of Pretoria at various levels— from research to being part of the working group compiling the national standards. He is a Fellow and present council member of the South Africa Institute of Engineering and Environmental Geologists.
Professor Van Rooy was an invited keynote speaker at the First International Conference on Education and Training in Geo-Engineering Sciences: Soil Mechanics and Geotechnical Engineering, Engineering Geology, Rock Mechanics that took place in Constanza, Romania, in 2008. In 2010 he co-authored a paper on ‘Granite weathering and the implications on infrastructure development in South Africa’ for the 11th Congress of the International Association for Engineering Geology and the Environment that took place in Auckland, New Zealand.
Among his most important recent publications is a co-authored article ‘Falling rock hazard index: a case study from the Marun Dam and power plant, south-western Iran’, published in the Bulletin of Engineering Geology and the Environment.
He also contributed to an article ‘Analysis of the occurrence and importance of slot development (grykes) within shallow dolomite zones in a selected type area on the Eccles Formation’ in the South African Journal of Geology
Professor Van Rooy received a C2 rating from the NRF.
Professor Venter obtained both the BSc and MSc (1984) degrees in Microbiology (Virology) at the University of the Free State (UFS). The area of research was virology, specifically the Rift Valley fever (RVF) virus. She received her PhD in 1993 with a thesis that dealt with the development of a group-specific diagnostic probe for the detection of the 24 serotypes for bluetongue virus (BTV). In 1988 she was appointed senior lecturer in the Department of Veterinary Tropical Diseases and promoted to professor in 2013.
Her research findings have been presented at 50 international and 86 national conferences. She is the author or co-author of 81 scientific publications and three book chapters. During the past five years she has produced 48 manuscripts for 12 different journals including the Onderstepoort Journal of Veterinary Research, Theriogenology, Medical and Veterinary Entomology, Veterinary Microbiology, and African Journal of Biotechnology She was a referee for nine NRF grant proposals and has assisted in the rating process of eight scientists. She has supervised or co-supervised 42 postgraduate students who successfully completed their degrees. She is currently co-supervising or supervising ten registered postgraduate students and one post doc fellow. She has been an external examiner for nine master’s and two PhD students, and internal examiner for four MSc and two PhD students.
Professor Venter received a C2 rating from the NRF.
Professor Visser is a professor of Psychology in the Faculty of Humanities.
The focus of her research in community psychology is to understand community dynamics underlying psycho-social problems. Using this knowledge, she then develops, implements and evaluates large-scale interventions to promote the psychological and social wellbeing in communities. Because of the prominent position of HIV/AIDS in communities, HIV prevention, care and support for the HIV-infected and -affected constitute a prominent part of her research. These projects include peer education as HIV prevention in schools, development of support structures for women living with HIV, the promotion of resilience in children affected by HIV and the development of a family-centred intervention for adolescents affected by HIV. Interventions in under-resourced areas involve the development and support of community workers to implement programmes and promote sustainability. Most of her research is of an applied nature and has practical value for many participants and communities. The research is often done in collaboration with multidisciplinary teams and international partners.
She has published 60 journal articles in peer-reviewed journals, 15 book chapters, 30 research reports, and delivered 73 national and 81 international conference papers. She is the editor of a prominent textbook on community psychology. She has supervised 40 master’s and 7 PhD students. She serves on the editorial board of and is a reviewer for several prominent psychology and health journals.
Professor Visser received a C2 rating from the NRF.
Dr Voigt is a Research Fellow in the Department of Zoology and Entomology in the Faculty of Natural and Agricultural Sciences. She received her PhD from the Ludwig Maximilian University of Munich, Germany, and joined UP as a Postdoctoral Fellow in 2012.
She is a neuroethologist and the broad scope of her research is to understand the proximate mechanisms of sex and social status-related differences in vertebrate behaviour. Her scientific approach comprises projects that integrate molecular, physiological and behavioural techniques under constrained and natural conditions. Her animal models include several bird species and the highly social mammals, African mole-rats. Her current research focusses on the neuroendocrine correlates of reproductive suppression in the Damaraland mole-rat.
In the past Dr Voigt has been awarded funding from prestigious sources such as the German Science Foundation (DFG) and the Max Planck Society. She is an associate editor of the journal Emu - Austral Ornithology and she has published more than 30 articles in international peer-reviewed journals, several of them in the high ranking journals of the Royal Society, Proceedings of the Royal Society of London B and Biology Letters
Dr Voigt received a C2 rating from the NRF.




Professor Voyi is an associate professor in the Division: Environmental and Occupational Health Sciences, Faculty of Health Sciences. She is the Chairperson of the School of Health Systems and Public Health.
Her research focusses on the effect of air pollution on the respiratory system as a contributing factor to the burden of non-communicable diseases. The approach is to address the interface of humans and their environment by adapting current methods for moving from evidence to recommendations in air quality and health. Her research uses exposure and epidemiological models on primary and secondary data. The research falls within the mandate of the Global Asthma Network on surveillance, management and advocacy to reduce the burden of asthma on children. Her research has contributed to the mapping of the burden of asthma in the world.
Professor Voyi’s research spans across disciplines and she collaborates with computer scientists, pulmonologists, geography and mathematical modelling groups. The end result of her research is two-fold, namely to contribute relevant information to the final air quality guideline document and to provide relief from respiratory diseases caused by exposure to air pollution. In 2016–2017 she was invited to participate in the WHO Air Quality Platform. In January 2018 she was invited to join the 57-member External Review Group (ERG 2018) for the update of WHO Global Air Quality Guidelines. She has supervised, MSc, MPH, MMed and PhD national and international students.
Professor Voyi received a C2 rating from the NRF.

Professor Webb is Deputy Dean (Research and Postgraduate Teaching) in the Faculty of Natural and Agricultural Sciences, and professor of production animal physiology in the Department of Animal and Wildlife Sciences. He obtained the degrees BScAgric (1988), BScAgric (Hons) cum laude (1989), MScAgric cum laude (1992) and PhD (1994) from the University of Pretoria, and conducted postdoctoral research at the University of Ghent in Belgium and Nutrico in the Netherlands in 1997. Outstanding academic achievements include a merit award from the Standard Bank of South Africa, UP postgraduate and merit bursaries, merit awards from the National Research Foundation, the AM Bosman Gold Medal, merit award from the South African Society for Animal Science, a bronze medal from the same society for his PhD thesis and a Fellowship from the Flemish Ministry of Agriculture and Fisheries in Belgium.
His postdoctoral research focussed on the effects of nutrition on fatty acid synthesis and aspects of growth-modelling in livestock. He subsequently continued his research in the field of production animal physiology at the University of Pretoria and was Head of Department from 2005 to 2016. His teaching and research currently focus on the effects of dietary factors and growth modifiers on animal growth, carcass and meat quality and animal reproduction. He has published 110 peer-reviewed scientific papers, presented 134 papers at conferences or symposia, written 30 technical reports, co-edited two books, contributed 17 book chapters, and 33 popular scientific papers. Professor Webb contributed to one registered patent. He is a registered professional animal scientist and served as president of the South African Society for Animal Science from 2009 to 2014.
Professor Webb received a C1 rating from the NRF.

Professor Wenhold is an associate professor in the Department of Human Nutrition, Faculty of Health Sciences. Her research area is nutrition assessment in South African populations, with a specific focus on anthropometric assessment and the development and validation of dietary assessment and screening tools for diverse target groups and settings. This is reflected in the studies currently conducted by her postgraduate students: growth monitoring of premature infants, conceptualisation and validation of an e-screening algorithm for the early detection of growth faltering in the community context, dietary intake of students and elderly people, and measurement and estimation of resting energy expenditure in different population groups. Ongoing research interests include the development and testing or validation of novel dietary assessment and portion size estimation aids for different settings.
Her most recent awards from the Nutrition Society of South Africa and the Association for Dietetics in South Africa (ADSA) relate to her research on portion size estimation aids.
Professor Wenhold received a C2 rating from the NRF.
Professor Zeiler is an associate professor in the Department of Companion Animal Clinical Studies, Faculty of Veterinary Science where he heads up the Section: Veterinary Anaesthesiology. His research foci are the chemical capture of wildlife and transfusion medicine in domestic cats and dogs. He and his postgraduate students investigate various drug combinations for the chemical capture of a wide range of wildlife species. A main focus is the pharmacodynamics of the drug combination on the captured animal’s cardiovascular and pulmonary systems and acid-base balance. An improved understanding of these processes will enable novel and safer drug combinations to be recommended. For domestic cats and dogs, he investigates the pathophysiological processes of acute haemorrhage and rapid fluid resuscitation. Cats have a unique physiological reaction and respond differently to fluid resuscitation compared to dogs. He has a particular interest in acid-base balance, cardiopulmonary integration and haemostasis.
He has received the Young Researcher Award from the Faculty of Veterinary Science and the Young Veterinarian of the Year Award from the South African Veterinary Association. Furthermore, he recently attained professional certification from the European and American College of Veterinary Anaesthesia and Analgesia Board.
Professor Zeiler received a C3 rating from the NRF.


Dr Biggs is a lecturer in the Department of Mathematics and Applied Mathematics in the Faculty of Natural and Agricultural Sciences.
His research focusses on the equivalence and classification of various (smooth) geometric structures. Dr Biggs has co-authored more than 30 papers involving research areas such as sub-Riemannian geometry, optimal control, Lie groups and Lie algebras, and Poisson spaces. Before joining the University of Pretoria in 2017, Dr Biggs was a Claude Leon Postdoctoral Fellow at Rhodes University. He still maintains close ties with the Geometry, Graphs and Control Research Group at Rhodes University.
Dr Biggs received a Y2 rating from the NRF.

Professor Deane is an associate professor in the Department of Physics in the Faculty of Natural and Agricultural Sciences, where he leads the newly formed radio-astronomy group.
His research interests include binary supermassive black holes, strong gravitational lensing and shadow detection of the supermassive black hole at the centre of our galaxy. In these pursuits he uses the technique known as very long baseline interferometry (VLBI), which combines signals received from radio antennas spread across the planet to form an earth-sized telescope. He employs this technique to conduct wide-field surveys of the universe and to perform detailed Bayesian inference of black hole physics. Both of these are big data challenges that will require strong cross-faculty collaboration with the University of Pretoria’s computational intelligence and machine learning groups. He is actively involved in South Africa’s MeerKAT telescope project, which is the precursor to the billion-dollar Square Kilometre Array (SKA) and will include antennas located across the African continent. In particular, he leads the MeerKAT-VLBI working group, which will enable MeerKAT to participate as one element in a global network of antennas.
Professor Deane received a Y1 rating from the NRF.

Dr De Vos is a Senior Postdoctoral Fellow in the Department of Biochemistry, Genetics and Microbiology in the Faculty of Natural and Agricultural Sciences.
She is a team member of the Tree Protection Cooperative Program (TPCP) within the Forestry and Agricultural Biotechnology Institute (FABI). Her research is focussed on the phytopathogenic species within the Fusarium fujikuroi species complex, specifically investigating species commonalities and differences by employing a genomics approach. Her work also encompasses investigations into species-specific traits and determination of the genes encoded by them. Dr De Vos has published numerous articles in international journals, and presented her research at international level.
Dr De Vos received a Y2 rating from the NRF.
Dr Fasselt holds a PhD from the Free University of Berlin, Germany, and is a lecturer in the Department of English in the Faculty of Humanities, where she teaches African and postcolonial literature. Her PhD thesis examined the portrayal of migrants from elsewhere on the African continent in contemporary South African writing. She is particularly interested in literary and cultural connections between South Africa and other parts of Africa, the short story in South Africa, as well as postcolonial narratives written in the first-person plural voice. Her recent publications can be found in English Studies in Africa, Research in African Literatures, Ariel, the Journal of Southern African Studies and Poetics Today.
Dr Fasselt received a Y2 rating from the NRF.
Dr Graham is a senior lecturer in the Department of Science, Mathematics and Technology Education in the Faculty of Education.
Her current research interests are statistical education and nonparametric statistics. She has published articles in numerous international accredited peer-reviewed journals and has presented her research at several national and international conferences. Her academic achievements have been rewarded with several bursaries from the University of Pretoria and the NRF. She has supervised more than 20 master's and PhD students. A recent academic highlight was a visit to the University of the Aegean in Samos, Greece, to structure a student exchange plan within the framework of the Erasmus agreement between the University of Pretoria and the University of the Aegean.
Dr Graham received a Y1 rating from the NRF.
Dr Kleynhans is an extraordinary senior lecturer in the Department of Electrical, Electronic and Computer Engineering. He received the PhD in Electronic Engineering from the University of Pretoria (2011), and an MBA from Heriot-Watt University, Scotland in 2012.
He is a statistical signal processing and machine learning expert focussing on the application areas of telecommunication, automated land cover change detection and maritime domain awareness using a variety of data sources. He has authored and co-authored more than 80 research papers in refereed accredited international conferences and journals. He has provided keynote talks, organised and chaired sessions, and also presented invited papers at various international conferences.
Dr Kleynhans’ most notable awards include best papers presented at the IEEE Geoscience and Remote Sensing Symposium (IGARSS) conference held in Munich in 2012, as well as the African Association of Remote Sensing of the Environment (AARSE) conference that was held in Morocco 2012. He is a past chair of the IEEE Aerospace and Electronics Systems and IEEE Geoscience and Remote Sensing local chapters. He is a principal inventor of the SeaFAR system, a data analytics platform utilizing advanced machine learning algorithms for maritime domain awareness that has been adopted on national level within the South African maritime security cluster.
Dr Kleynhans received a Y1 rating from the NRF.




Dr Marufu is a senior lecturer in the Department of Production Animal Studies and Head of the Production Animal Clinic. He has a strong focus on the epidemiology of vectors, vector-borne diseases and parasites of ruminants, particularly in the smallholder sector with an outlook on the possible effect of climate change and its influence on disease and parasite distribution. His goal is to investigate the genetic basis for resistance to ticks in cattle with the hope of identifying markers for resistance which may be useful in vaccine development or for recombination gene technologies in the future.
Dr Marufu received a Y2 rating from the NRF.

Dr Niemand is a senior lecturer in the Department of Biochemistry, Genetics and Molecular Biology in the Faculty of Natural and Agricultural Sciences.
She is an active member of the University of Pretoria Institute for Sustainable Malaria Control and the Tuks Young Research Leader Programme. Following the completion of a Claude Leon Postdoctoral Fellowship, she left academic research for 14 months to work as a clinical research associate to broaden her knowledge on drug development and clinical trials in South Africa. In 2014 she returned to UP as co-investigator of the SARChI Chair in Sustainable Malaria Control. Her research focusses on the biology of the human malaria parasite with a particular interest in unique and essential parasite processes targetable in sustainable malaria control strategies. Her current research interests include nutrient uptake in both the asexual and sexual stages of malaria parasites and a systems-level understanding of the malaria parasites’ phenome. This phenotypic analysis of malaria parasites not only focusses on the pathogenic asexual forms of the parasite, but also includes the novel nutrient uptake processes of the transmissible form of the malaria parasite, for which she was awarded a prestigious L’Oréal-UNESCO For Women in Science Sub-Saharan Africa Fellowship (2016).
Dr Niemand received a Y2 rating from the NRF.

Dr Swanepoel is a Senior Postdoctoral Fellow in the Department of Physiology in the Faculty of Health Sciences. Her research focusses on female health, in particular the impact of natural and synthetic hormones on blood coagulation.
After completing her PhD in the Department of Physiology in 2013, she entered into an NRF Scarce Skills Postdoctoral Fellowship in the same department in January 2014 and completed her term in December 2016. In January 2017 she commenced with her University of Pretoria Senior Postdoctoral Fellowship.
She has used both viscoelastic analysis as well as morphological techniques, specifically electron microscopy (ZEISS High resolution CryoSEM at the Microscopy and Microanalysis Unit), to establish the specific influence of the abovementioned hormones on whole blood and plasma fibrin networks. To date she has published 23 articles in international ISI-accredited, peer-reviewed journals. In 2014, she received the Faculty of Health Sciences award for the Best Publication by a Young Researcher (under the age of 35) in the Clinical Category for her paper titled ‘Erythrocyte-platelet interaction in uncomplicated pregnancy’.
Dr Swanepoel received a Y2 rating from the NRF.
Dr Vermeulen is the research manager and a Postdoctoral Research Fellow of the Mammal Research Institute Whale Unit of the Department of Zoology and Entomology. Furthermore, she is a national delegate to the International Whaling Commission and an invited member of the International Union for Conservation of Nature (IUCN) Cetacean Specialist Group.
As a marine mammal specialist Dr Vermeulen´s expertise lies in the field of population biology and includes population structures and dynamics, ethology, and ecology - the role of marine mammals, often as apex predators, within their environment. Her main objectives relate to understanding the causal factors affecting marine mammal conservation in order to enhance conservation management strategies.
Although being primarily a natural scientist, Dr Vermeulen strongly believes in a multidisciplinary approach to face the challenges within marine conservation. Therefore she has a strong focus on establishing collaborations among different research groups and stakeholders. In 2017 she established a South African national research consortium with a focus on Indian Ocean humpback dolphins (SouSA Consortium) facilitating a national collaboration among researchers to improve the accuracy of scientific data and appropriately advise conservation management.
Dr Vermeulen´s current research focus is the post-whaling recovery of large baleen whales in the Southern Ocean, especially southern right whales, building on a nearly 40-year old database.
Dr Vermeulen received a Y2 rating from the NRF.
Dr Visagie is an NRF Scarce Skills Postdoctoral Fellow (2016 to present). In 2014 she completed a PhD at the University of Pretoria with a thesis titled ‘Differential anticancer signalling exerted by an in silico-designed compound in tumourigenic and nontumourigenic breast cells’. Her research on human physiology led to postdoctoral research with Professor Annie Joubert on in silico-designed anti-cancer drugs from 2014 to 2016.
Dr Visagie initiated her own research projects focussing on cell death induction via reactive oxygen species (ROS), which she is currently studying in multiple ways. She aims to identify the targets of ROS resulting in decreased proliferation and cell death induction in different circumstances.
Dr Visagie has published several articles in peer-reviewed internationally recognised journals, including Plos One, Cancer Chemotherapy and Pharmacology, Cell & Biosciences and Cancer Cell International. She has collaborated with national and international academic researchers from the Centre for Research and Continued Engineering Development and the Institut Albert Bonniot in Grenoble, France, as well as locally in the private industry with NextBiosciences.
Dr Visagie received a Y2 rating from the NRF.
Professor Vorster is a nuclear medicine physician at the University of Pretoria’s Department of Nuclear Medicine, where she is jointly employed as Head of Clinical Unit and associate professor.
Her PhD-related research involved the use of a to-date under-utilized generator-based positron emission tomography (PET or PET scan) tracer, gallium-68 citrate, in a novel setting. In South Africa, patients with lung lesions often present clinicians with a diagnostic challenge, especially in the presence of co-infection with HIV. Such lung lesions may represent a wide spectrum of benign (frequently tuberculosis) and malignant conditions that often require a histological diagnosis following an invasive procedure. The use of gallium-68-based PET tracers makes sense in the South African context, as these are fairly readily available and cost effective. It has also sparked her interest in other possible gallium-68-based applications to solve clinical challenges that are unique to the South African setting.
Professor Vorster has received the following awards as a result of her PhD-related research: the Chris Jansen Young Researcher Award, Best Oral Presentation at IRIST meeting (WFNMB Mexico), academic honorary colours from the University of Pretoria, Best Presentation at the 2nd Medical Olympiad in Greece and an invitation to contribute to Seminars in Nuclear Medicine.
Professor Vorster received a Y2 rating from the NRF.




Dr Zang is a senior lecturer and the incumbent of a Junior Chair on Energy Efficiency funded by Exxaro in the Department of Electrical, Electronic and Computer Engineering.
He obtained an MEng degree from the Wuhan University, China in 2012, and subsequently completed a PhD at the University of Pretoria in 2016.
He is an accredited South African National Accreditation System (SANAS) technical signatory for the measurement and verification of energy savings and is registered with the Engineering Council of South Africa (ECSA) as a professional engineer. He has published more than 30 research articles in internationally highly reputable journals and conferences to date. His research interests include energy modelling, optimisation and control system design for industrial processes, heavy-haul trains, electric vehicles, building energy systems and micro-grids, etc.
Dr Zhang received a Y2 rating from the NRF.